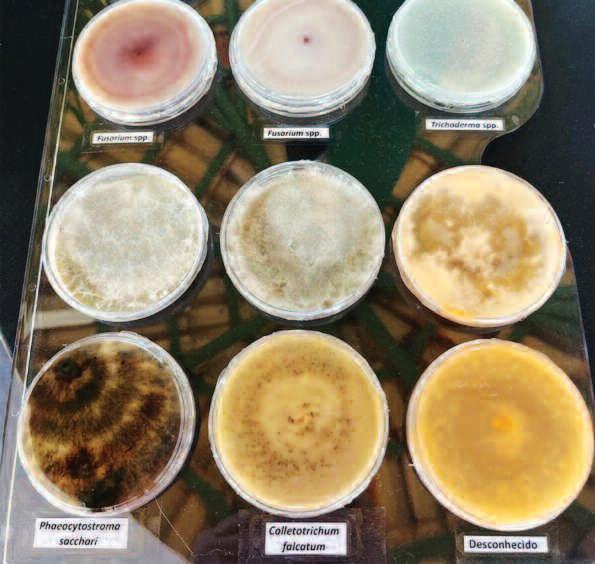
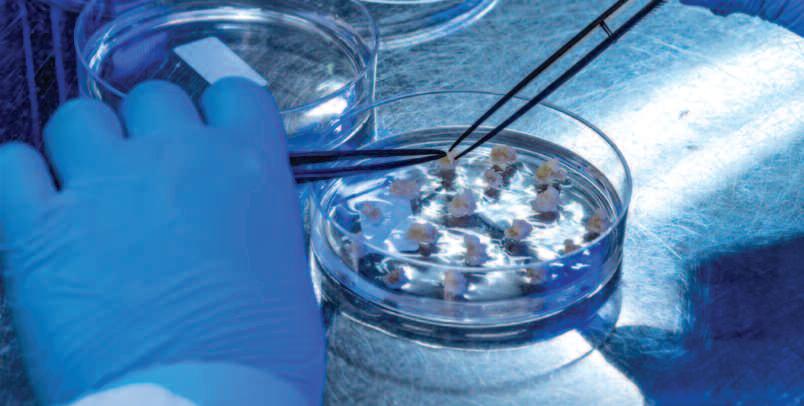

índice
MERCADO
car ta ao leitor
Andréia Vital - redacao@procana com br

















Andréia Vital - redacao@procana com br
Os insumos biológ icos estão se tor nando, cada vez mais, essenciais para o cultivo de canaviais Eles aumentam a produtividade, promovem a saúde das plantas e do solo, reduzem o uso de fer tilizantes químicos e pesticidas, e contr ibuem para a sustentabilidade ag rícola Esses insumos estão alinhados com a busca por uma ag r icultura mais sustentável e têm impactos positivos no meio ambiente e na saúde humana Em resumo, são fundamentais para o sucesso dos canaviais e para a produção de açúcar e etanol de for ma sustentável
A edição de Junho/Julho do Jor nalCana tem como destaque a histór ia de um produtor com tradição de mais de 50 anos no setor sucroenergético, da reg ião de Piracicaba SP, conhecida por seus solos arenosos de classificação D e E, e nos últimos anos com baixo índice pluviométr ico, alcançou resultados expressivos após incluir o Adubo Biológ ico produzido com Microgeo® em seu manejo padrão em suas propr iedades
Ainda sobre o tema, o leitor encontra uma sér ie de matér ias com infor mações de especialistas e representantes de usinas e empresas que par ticiparam do CANABIO23 – Em busca da Cana Regenerativa, realizado no Centro de Cana IAC em Ribeirão Preto – SP, nos dias 24 e 25 de junho
Ainda nesta edição, uma matér ia do Delcy Mac Cr uz abordando a questão do “capturar e enter rar gás carbônico entra no radar do setor sucroenergético” A tecnolog ia per mite a negativação de emissões e valor iza os créditos de descarbonização e uma entrevista exclusiva com o engenheiro químico Jaime Finguer ut “A total clareza da venda do carbono nestes novos mercados é o que definirá se iremos ou não escalonar esta tecnolog ia nos próximos anos É algo f actível e o setor precisa ser ág il em conseguir a regulação e valor izar este produto, como o fez no passado com a bioeletr icidade (uso do bagaço e da palha)”, explica o especialista
A edição de junho/julho mostra também que as companhias voltaram a investir para ampliar a sua produção, como case das Usinas Santa Mar ia, na Bahia e São Domingos, em São Paulo E que outras, estão conseguindo se reerguer, após passar por períodos de recuperação judicial, como a Usina Moreno, que liquidou o saldo das operações DIP Finance contratadas no encer ramento do processo de recuperação judicial, que ocor reu, antecipadamente, há cerca de 1 ano e meio Mostra também os investimentos em novas tecnolog ias, tais como o DT Faceum, uma fer ramenta de reconhecimento f acial produzida pela Dimastec, que está sendo implantada em todas as suas unidades A tecnolog ia reduz custos e traz mais ag ilidade no reg istro de ponto dos funcionár ios Além disso, o leitor encontra uma sér ie de matér ias sobre o prog resso do uso do biometano no Brasil, com testes em ônibus urbanos, através de uma iniciativa pioneira da Companhia Paranaense de Gás (Compagas), em parcer ia com a Prefeitura de Londr ina e a Scania E também mostra que os produtores r urais começaram a investir no combustível, sendo que o pr imeiro trator movido a biometano no Brasil foi vendido para uma f azenda em Mato Grosso do Sul, inaugurando um novo segmento de máquinas ag rícolas e marca o início de uma nova etapa na busca pela transição energética no país
É muito conteúdo interessante
Boa leitura!
COMITÊ DE GESTÃO EQUIPE
ISSN1807-0264


+55 16 99635-3205
Av. Costábile Romano, 1.544 - Ribeirânia 14096-030 - Ribeirão Preto -SP atendimento@procana.com.br
“ Desenvolver o agronegócio sucroenergético, disseminando conhecimentos, estreitando relacionamentos e gerando negócios sustentáveis"
Presidente
Josias Messias josiasmessias@procana.com.br
Lucas Messias Mateus Messias João Pedro Messias presidente@procana.com.br
Editora
Andréia Vital - (16) 9 9279.4155 redacao@procana.com.br

Produtos Digitais & TI Alessandro Reis - (48) 9 2000.4934 editoria@procana.com.br
Diagramação
Porão das Idéias Murad Badur - (19) 9 8173.3268 diagramacao@procana.com.br
Atendimento Mídias & Eventos
Assinaturas & Exemplares +55 16 99635-3205 atendimento@procana.com.br www.procanaloja.com.br
Financeiro Renata Macena
marketing@procana.com.br fi nanceiro@procana.com.br
Artigos assinados (inclusive os da seções Negócios & Oportunidades e Vitrine) re fl etem o ponto de vista dos autores (ou das empresas citadas). Jornal Cana: direitos autorais e comerciais resera vados. É proibida reprodução, total ou parcial, distribuição ou disponibilização pública, por qualquer meio ou processo, sem autorização expressa.
A violação dos direitos autorais é punível como crime (art. 184 e parágrafos, do Código Penal) com pena de prisão e multa; conjuntamente com busca e apreensão e indenização diversas (artigos 122, 123, 124, 126 da Lei 5.988 de 14/12/1973).

Em resumo, trata se de um siste ma que associa empregos da energ ia de biomassa à captura e ar mazena mento de carbono, processo realizado sempre em g rande escala
Com isso, é possível sequestrar o carbono presente na atmosfera
D e s p o n t a n o s e t o r s u c ro e n e r g é t i c o u m a t e c n o l og i a , o u c o n j u n t o d e t e c n o l o g i a s , q u e r e f o r ç a r á o p o d e r d e d e s c a r b o n i z a ç ã o d o e t a n o l , s e j a e l e f e i t o d e c a n a d e a ç ú c a r o u d e m i l h o
Aliás, se o setor já venceu a gaso lina em ter mos de redução de carbo no (CO2) emitido, com médios 70% a f avo r d o b i o c o m bu s t í ve l , a g o r a e l e tem chances de simplesmente nega tivar o carbono gerado
Essa tecnolog ia atende pelo nome de BECCS, sigla para Biomass Ener gy with Carbon Capture and Stora ge, traduzido para o por tuguês como Sistemas de Bioenerg ia com Captura e Ar mazenamento de Carbono
Vale destacar que o CCUS (do inglês Carbon Capture, Utilization and Storage), ‘parente’ do BECCS pa ra remover CO2 da atmosfera em ou tros setores industr iais, há anos foi im plantado
A Pe t ro b r a s , p o r e xe m p l o, re a l i z a a p r á t i c a d e c a p t u r a d e c a r b o n o h á m a i s d e 1 0 a n o s E m 2 0 2 2 , re i n j e t o u 1 0 m i l h õ e s d e t o n e l a d a s d e C O 2 e m s e u s c a m p o s , o q u e, c o n f o r m e a e m p re s a , re p re s e n t a 2 5 % d e t o d o o vo l u m e d e c a p t u r a d e c a r b o n o d o mu n d o
Agora a Petrobras começa a olhar essa captura como negócio, já que co nhece par ticular idades da operação, como a interação do gás com os du tos em ter mos de cor rosividade
Em recente evento, representantes da empresa lembraram que o custo dessa tecnolog ia ainda é caro, mas que
tecnolog ias como a eólica e a solar precisaram de incentivos para come çar a ser utilizadas
Já o setor sucroenergético no Bra sil deve estrear na tecnolog ia a par tir da FS (do inglês Fueling Sustainabili ty), controlada pela Summit Brazil Renewables I, LLC
Produtora de etanol de milho com duas unidades em produção e uma terceira em f ase final de implantação, todas no Mato Grosso, a FS empreen de projeto BEECS na planta de Lucas do Rio Verde
Para tanto, a empresa investe per to de R$ 300 milhões para que, em hor izonte de 2030, chegue a ter pe gada negativa via BECCS e ar mazene
negativos 13 g ramas de CO2 para ca da mega Joule de energ ia gerado na queima (contra atuais 17 g ramas)
O projeto pioneiro da FS está na f ase de levantamentos geológ icos na reg ião de Lucas do Rio Verde e, con for me apurado pelo Jor nalCana, en volverá a escavação de poços de estu do nesta reg ião do Mato Grosso
Mais sobre a tecnologia
O futuro (rápido) da captura e ar mazenamento de CO2 é promissor
Para se ter ideia, em 2021 o insti tuto científico Global CCS estimava em 27 as plantas de CCUS operacio nais no mundo, a maior ia em países desenvolvidos, em especial nos EUA

A saber : o CO2 gerado por essas plantas é capturado e injetado em for
Para saber mais a respeito do sistema BECCs, Jor nalCana entre vista o engenheiro químico Jaime Finguer ut
Diretor e membro do conselho do Instituto de Tecnolog ia Cana vieira (ITC), ele tem pós g radua ção em Engenhar ia Bioquímica e especializou se em temas do setor com ênf ase em bioprocessos, atuan do pr incipalmente em etanol celu lósico, leveduras, biocombustíveis e em fer mentação alcóolica

Qual é a importância d do sisstema a BECCs para o settor s sucroenerrggéticoo? ?
J Ja a i m e F i n g u e r u t A c r ô n i m o q u e e m i n g l ê s s i g n i f i c a B i o e n e r g i a c o m C a p t u r a e A r m a z e n a m e n t o d e C a r b o n o ( C O 2 ) , o s i s t e m a
B E C C S é u m a p a r t e i m p o r t a n t e d a s e s t r a t é g i a s mu n d i a i s p a r a D e s c a r b o n i z a ç ã o
No entanto, como é uma solu ção de engenhar ia, ela gera poten cialmente menos impactos positivos do que outras práticas baseadas na natureza como plantação ou con ser vação de florestas
C o m o n o p ro c e s s a m e n t o d e c a n a o u d e m i l h o g e r a m o s e n o r m e s q u a n t i d a d e s d e C O 2 , 1 0 0 %
Tecnologia permite a negativação de emissões e valoriza os créditos de descarbonização
radar do setor
Com baixo custo, setor tem oportunidade de negativar as emissões
mações geológ icas profundas, onde fi ca per manentemente ar mazenado
Mas, calma lá: não é tão simples como pode parecer
No Brasil, o BECCS é tema re cor rente de eventos científicos Em 2019, por exemplo, foi tema de workshop organizado pelo Fapesp Shell Research for Gas Innovation (RCGI), IEE/USP e pelo Consulado Geral dos Países Baixos, com patrocí nio da FAPESP
A razão pr incipal do workshop foi analisar a necessidade de tais tecnolo g ias para reduzir as emissões de car bono e os desafios existentes para sua implementação, explicaram os orga nizadores do evento realizado há qua tro anos
O público alvo do evento foram
p rove n i e n t e s d a b i o m a s s a e m a i s a i n d a , t e m o s o C O 2 d a f e r m e n t a ç ã o a l c ó o l i c a ( 1 : 1 e m p e s o c o m o e t a n o l ) q u a s e p u ro ( > 9 7 % d e p u re z a ) , t e m o s u m a e n o r m e o p o r t u n i d a d e d e " c a p t u r á l o " e " e n t e r r á l o " c o m b a i x o s c u s t o s , re d u z i n d o s i g n i f i c a t iva m e n t e a s e m i s s õ e s , a t é t o r n á l a s n e g a t iva s
Em linhas ger a aiss, como o f funccioona esse sistem a?
Tr a t a s e d e " c a p t u r a r " o C O 2 g e r a d o n a c o nve r s ã o d a b i o m a s s a (cana, milho, bagaço, palha, etc ) em b i o e n e r g i a ( p ro d u ç ã o d e e t a n o l , b io e l e tr i c i d ad e, o ut ros b i o c o m bu s tíveis) , da fo r ma mais pura possível, pressur iza lo, colocá lo em tubula ções para levá lo até um poço pro fundo (com mais ou menos 2 quilô m e t ro s d e p ro f u n d i d a d e ) o n d e e s t e C O 2 s e r á m a n t i d o e m re s e r va t ó r i o g e o l ó g i c o s s e g u ro s p o r c e n t e n a s o u milhares de anos
professores, pesquisadores e integ ran tes dos times de P&D de empresas como Shell, Petrobras e Comgás, além do setor sucroenergético
Aliás, setores como os de petróleo e gás brasileiros são focos de projeto do RCGI Implantado em 2021, ele tem por objetivo identificar, caracte r izar e modelar as pr incipais unidades geológ icas da bacia sedimentar ter res tre do Paraná com potencial para ar mazenar CO2 com segurança
Os resultados desse projeto, con for me os organizadores, devem con tr ibuir para o alcanc e das emiss ões negativas de CO2 pelas usinas de eta nol do Estado de São Paulo
No caso, são avaliados potenciais reser vatór ios geológ icos passíveis de adsor ver (adesão de moléculas de um
E Em q quue setores indust r iais ele j á é globa l lmennt e aplica do?
Há mapeadas cerca de 47 insta lações em funcionamento no mun d o, a r m a z e n a n d o c e rc a d e 7 0 m i lhões de toneladas de CO2 por ano, s e n d o d i g n o d e n o t a o s i s t e m a d e Captura e Ar mazenamento de Car bono (CCS) de uma bior refinar ia de m i l h o n o s E UA , n a re g i ã o d e p ro d u ç ã o d e e t a n o l , d a e m p re s a A D M e m D e c a t u r, e s t a d o d e I l l i n o i s , q u e opera desde 2011
Há centenas de projetos de Cap tura e Ar mazenamento pelo mundo, mas sua viabilidade depende das po líticas de promoção da Descarboni zação (Mercado de Carbono)
T Teem o s t te cn ol og i a n aci on a al pa ra em m p reee e n nd e er u m si st e ma a B E C CCs n o settoor r ? No que se refere à tecnolog ia, embora não exista ainda a p r imeira instalação no país, podemos dizer que
fluido a uma superfície sólida) quan tidades significativas de CO2 compa tíveis com a quantidade liberada nas atividades de produção de etanol Como se vê, o tema BECCS avança em ter mos científicos Mas também avança a seu r itmo em ter mos de regulação
A regulação da captura e ar maze namento de carbono no Brasil, que contempla o sistema BECCS, integ ra, por exemplo, projeto de lei em trami tação no Cong resso
Trata se do Projeto de Lei 1425, de 2022, de autor ia do senador licen ciado (hoje presidente da Petrobrás), Jean Paul Prates, que “disciplina a ex ploração da atividade de ar mazena mento per manente de dióxido de carbono de interesse público, em re ser vatór ios geológ icos ou temporár ios, e seu poster ior reaproveitamento ”
Esse PL obteve, em 06 de junho último, aprovação da Comissão de In fraestr utura (CI) do Senado
No parecer, a Comissão relata que “ o setor de biocombustíveis é agente impor tante nesse processo, pois, a par tir da implementação d o CCS nas plantas de etanol, é possível se produ zir combustível que reduz emissões de dióxido de carbono ”
Esse efeito é potencializado caso se aplique também a usinas ter melétr icas à biomassa ou à biocombustível, emenda
“O processo em questão é deno minado Bioenerg ia com CCS (ou BECCS) e possui impor tante papel na retirada de dióxido de carbono da at mosfera, especialmente após 2050, se

sim, temos conhecimento de enge nhar ia no Brasil nesta área tendo em vista o desenvolvimento nacional do Pré Sal e o f ato da Petrobras já rein jetar gás natural (e CO2) nos poços profundos para aumentar a recupe ração de óleo
O s f o r n e c e d o r e s d e s o l u ç õ e s d e e n g e n h a r i a d a Pe t ro b r a s p o d e r ã o t r a b a l h a r n o s e t o r d e p ro d u ç ã o d e e t a n o l e p r ove r s o l u ç õ e s d e f o r m a r á p i d a
F Foor r a os ga nhos s a am bienttais que o B BE CCCS ger r a à em p r res a innvves ti i do r a, t em a m o n ne t i iza çã ã o Com m o c co me r c cia a l lizzaar e esse caar bono neggaat ivo?
O RenovaBio já prevê um bônus adicional aos créditos de descarboni zação (CBIOs) no caso do produtor comprovar as suas emissões negativas, que ser iam conseguidas com o BECCS
No entanto, o escalonamento desta prática dependerá de outros
gundo os cenár ios da Agência Inter nacional de Energ ia (AIE)”, conclui o texto do parecer
Presente à reunião da Comissão, o p re s i d e n t e d a U n i ã o N a c i o n a l d o Etanol de Milho (Unem), Guilher me N o l a s c o, a p o n t o u q u e o s e t o r d e b i o c o m bu s t í ve i s a p a r t i r d o m i l h o ser ia capaz de capturar até 320 kg d e C O 2 p a r a c a d a t o n e l a d a d e m i l h o processada
Ele ressaltou, ainda, que a garantia de liberdade para desenvolver e mo netizar os projetos se mostra como as pecto impor tante para a matur idade da atividade de CCS
Após a aprovação pela Comissão de Infraestr utura, o texto está agora com a Comissão de Meio Ambiente do Senado
Em que pese o r itmo da tramita ção, existe u ma torcida pela entrada em prática da regulamentação, até porque, confor me projeções, a ativi dade pode render até US$ 20 bilhões às empresas brasileiras, entre elas pro dutores de etanol
É cer to que, mesmo com a regu lamentação, há a questão dos altos custos para capturar, transpor tar e ar mazenar o CO2
Em tempo: o Brasil possui reg iões que podem ter os chamados hubs de injeção de gás
Uma delas é a reg ião da Bacia do Paraná, que possui 1,3 milhão de qui lômetros quadrados e se estende por Brasil, Paraguai, Ur uguai e Argentina Do lado brasileiro, a bacia contempla, confor me especialistas, a maior par te da produção de etanol de cana
mecanismos adicionais de valor iza ção do Carbono não emitido, como a venda de Créditos de Carbono no mercado voluntár io, que hoje valem em tor no de U$ 10 a tonelada
É muito menos do que os CBIOs, ou muito mais (U$ 100 200 / tonelada) nos mercados regu lados, que ainda não existem no Bra sil e demorarão muitos anos para chegarem ao setor sucroenergético, até uma completa regulação gover namental desta prática
É a re gulam ent açã o d o meercado que ir á def inir o os r umos do BECCS?
A total clareza da venda do car bono nestes novos mercados é o que definirá se iremos ou não escalonar esta tecnolog ia nos próximos anos
É algo f actível e o setor precisa ser ág il em conseguir a regulação e va lor izar este produto, como o fez no passado com a bioeletr icidade (uso do bagaço e da palha)
Uma recente pesquisa realizada na Unicamp liderada pelo pesquisador Marcelo Gauto e publicado no início de junho em ar tigo na revista cientí fica Energy for Sustainable Develop ment, da editora Elsevier, traz novos números sobre emissões de CO2 de veículos a combustão (ICEV), híbr i dos fechados (HEV), híbr idos recar regáveis plug in (PHEV) e 100% elé tr icos (BEV, Batter y Electr ic Vehicle), usando gasolina pura, etanol, biome tano ou eletr icidade A p e s q u i s a l evo u e m c o n s i d e r a ç ã o a m a t r i z e n e r g é t i c a b r a s i l e i r a e a s e m i s s õ e s c o m u s o d e d i f e re n t e s t i p o s d e e n e r g i a d o b e r ç o à ro d a , o q u e i n c l u i t u d o q u e f o i e m i t i d o n a f a b r i c a ç ã o d o s ve í c u l o s – e d a s b a t e r i a s n o c a s o d o s e l é t r i c o s e h í b r i d o s – ; n a p ro d u ç ã o, d i s t r i bu i ç ã o e q u e i m a d e g a s o l i n a p u r a , e t a n o l p u ro e g á s b i o m e t a n o ; n a g er a ç ã o d e e l e t r i c i d a d e e i n f r a e s t r u t u r a d e re c a r g a p a r a P H E V s e B E V s
Este novo estudo traz à tona nú meros que ampliam ainda mais a van tagem do híbr ido flex sobre c ar ros 100% elétr icos a bater ia.
Levando em conta a matr iz ener gética mais limpa do Brasil, cerca de 80% composta por fontes renováveis de usinas hidrelétr icas, eólicas e sola
res, pesquisas já apresentadas mostra vam que um híbr ido flex, quando abastecido só com etanol, tem emis sões de CO2 pouco infer iores às de um car ro 100% elétr ico
O estudo realizado na Unicamp amplia esta medição: além de consi derar as emissões na produção e uso do combustível também leva em con ta o que é emitido durante o proces so de produção do veículo, das bate r ias – no caso de híbr idos e elétr icos –e até mesmo da instalação da infraes tr utura de recarga para modelos 100% elétr icos ou híbr idos plug in
Os resultados das projeções de emissões do berço à roda dão ampla vantagem a f avor dos biocombustíveis, pr incipalmente o gás biometano. Se gundo o estudo, levando em conta to do o ciclo de vid a da produção do veículo ao seu uso, um car ro rodando com gasolina pura emite 269,3 g ramas
de CO2 equivalente por quilômetro (gCO2e/km), enquanto o mesmo veículo a combustão com etanol E100 emite menos da metade, 120,9 gCO2e/km, ou três vezes menos, 73,6 gCO2e/km, com gás biometano

Um híbr ido fechado HEV, que se auto car rega só com o motor a com bustão, é a combinação mais susten tável, emite ainda menos quando usa só biocombustíveis: 77,5 gCO2e/km com E100 e 59,5 gCO2e/km com biometano – este foi o melhor resul tado do estudo
Os híbr idos plug in, recar regável na tomada, perdem par te da vantagem porque usam mais a propulsão elétr i ca e precisam de bater ias maiores, que emitem mais CO2 na produção: com E100 um PHEV emite 91,4 gCO2e/km e com b iometano 85,8 gCO2e/km Ainda assim são números melhores do que um car ro a combus

tão com eta nol, mas piores do que motores alimentados por biometano Já um BEV, 100% elétr ico a bate r ia, segundo o estudo levando em conta seu ciclo de vida emite 104,8 gCO2e/km quando alimentado pela matr iz energética brasileira, mais de 80% dela renovável Ainda assim o re sultado é pior do que qualquer híbr i do combinado com etanol ou biome tano ou mesmo um veículo a com bustão abastecido só com biometano Como comparação, se fosse recar regado na Europ a, mais de 70% de pendente de usinas tér micas alimen tadas por combustíveis fósseis, este mesmo BEV emitir ia 145,6 gCO2e/km, número que só é melhor do que um automóvel a gasolina, o que tor na a opção de eletr ificar a fro ta uma escolha necessár ia só para paí ses que n ão têm dis ponibilidade de biocombustíveis
D e a c o rd o c o m o p re s i d e n t e d a U n i ã o d a I n d ú s t r i a d e C a n a d e A ç ú c a r e B i o e n e r g i a ( U N I CA ) , E va n d ro G u s s i , p a r a c r i a r u m a re d e d e a b a s t e c i m e n t o d e c a r ro s e l é t r i c o s no Brasil ser iam necessár ios investi m e n t o s d e R $ 1 t r i l h ã o a t é R $ 1 , 5 tr ilhão Por sua vez, a rede de etanol já está pronta e funcionando em mais d e 4 0 m i l p o s t o s d e c o m bu s t í ve i s , e n t re g a n d o p r a t i c a m e n t e o m e s m o d e s e m p e n h o e m t e r m o s d e d e s c a r b o n iz a ç ã o, al é m d e ge r a r e m p re g o e renda em mais de 1,2 mil municípios “ Te m o s u m s i s t e ma d e d i s t r i bu i ç ã o, l og í s t i c a e va re j o e m 1 0 0 % d o t e r r i t ó r i o n a c i o n a l , c o m u m a p re
s e n ç a a g ro i n d u s t r i a l e m m a i s d e 1 , 2 m i l c i d a d e s E n t ã o j á e s t a m o s e n t re g a n d o e s s a d e s c a r b o n i z a ç ã o s e m c u s t o p a r a a s o c i e d a d e b r a s i l e i r a , e m a i s d o q u e i s s o, g e r a n d o e m p re g o e re n d a e m m a i s d e 1 , 2 m i l mu n i c í p i o s ” , a r g u m e n t o u
Gussi lembrou que os municípios q u e p o s s u e m u s i n a s ve e m u m a u mento de US$ 1 028 por ano no PIB p e r c a p i t a e n o s v i z i n h o s , o a u m e n t o s e r i a d e U S $ 3 2 4 p o r a n o “ A e l e t r i f i c a ç ã o n ã o m e l h o r a a d e s c a r b o n i z a ç ã o n o B r a s i l , e n t re g a o q u e a g e n t e j á t e m , n ã o i n c re m e n t a d e m o d o re l eva n t e C o m o e t a n o l , h o j e vo c ê a b a s t e c e s e u c a r ro n o
p o s t o d e c o m b u s t í ve l e m q u a t ro a c i n c o m i n u t o s Pa r a f a z e r a l g o s e m e l h a n t e c o m e l e t r i f i c a ç ã o, o u s e j a , t e r t o d a e s s a d i s p o n i b i l i d a d e e m
C u r i t i b a – P R o u e m C r a t o – C E , a e m p re s a p ú bl i c a E P E c a l c u l o u q u e o c u s t o d e s s a i n f r a e s t r u t u r a va r i a r i a d e
U S $ 2 2 0 b i l h õ e s a U S $ 3 0 0 b i l h õ e s ” , a f i r m a E l e a i n d a c o m p l e t a : “ O u s e j a , a s o c i e d a d e b r a s i l e i r a t e r i a d e e s t a r d i s p o s t a a g a s t a r a l g o e n t re R $ 1 t r i l h ã o e R $ 1 , 5 t r i l h ã o A p e r g u n t a é : o c i d a d ã o b r a s i l e i ro va i t i r a r e s s e d i n h e i ro d o b o l s o e i s s o va i m e l h o r a r a e m i s s ã o d e C O 2 ? N ã o Va i s e r o q u e a g e n t e j á t e m h o j e c o m o e t a n o l ”
A pesquisa levou em consideração a matriz energética brasileira e as emissões com uso de diferentes tipos de energia do berço à roda
O presidente da União da Indús tr ia de Cana de Açúcar e Bioener g ia (UNICA), Evandro Gussi, defen deu que os avanços obtidos com a Emenda Constitucional 123 sejam preser vados na refor ma tr ibutár ia
No ano passado, o Cong resso Na cional aprovou a proposta de emenda à Constituição que previa um reg ime fiscal diferenciado para os biocom bustíveis, como o etanol, em relação aos combustíveis fósseis A medida equacionou a perda de competitivi dade diante de ajustes nas alíquotas dos combustíveis, estabelecidos para redu zir o preço final de gasolina e diesel
“O g rande avanço da refor ma tr i butár ia neste tema está em trazer o di ferencial de competividade entre os biocombustíveis e a gasolina para o direito ambiental, que é um direito


fundamental na Constituição”, afir mou o presidente da UNICA, que par ticipou de audiência pública na Câmara dos Deputados em junho,
realizada por iniciativa do deputado federal Reg inaldo Lopes, presidente do Gr upo de Trabalho da Refor ma Tr ibutár ia
“De acordo com a EC 123, uma lei complementar poderá avançar nes se aspecto, então temos uma opor tu nidade para o Brasil, porque o mundo está precisando de bioenerg ia”, desta cou Evandro Gussi Durante a audiênc ia, o consult or jurídico da UNICA, Leo Amaral, des tacou alguns pontos de atenção para os marcos regulatór ios em discussão no Parlamento, entre eles, a compatibili dade da refor ma com a competivida de do etanol em nível constitucional; o “ponto ótimo” entre melhores prá ticas ar recadatór ias e a preser vação de competividade; e a simplificação de apuração e ar recadação
A audiência pública contou com a par ticipação do deputado federal Ar naldo Jardim e de represen tantes do setor de biocombustíveis, como o presidente do Fór um Nacional Su croenergético (FNS), Már io Campos, o diretor super intendente da Associa ção dos Produtores de Biocombustí veis do Brasil (Aprobio), Julio Cesar Minelli, e o presidente da União Na cional do Etanol de Milho (Unem), Guilher me Nolasco

buindo para a meta global de redução de emissões Em 2022, o Parlamento Europeu classificou o gás natural co mo um "investimento verde" No Brasil, existe uma g rande opor tunida de de substituir o uso de diesel por gás natural e biometano, o que resultar ia em benefícios ambientais, sociais e econômicos significativos
O mercado de gás alcançou um marco impor tante com uma iniciati va pioneira da Companhia Paranaen se de Gás (Compagas), em parcer ia com a Prefeitura de Londr ina e a Sca nia: o pr imeiro teste no Brasil de um ônibus urbano, totalmente movido a biometano, integ rado ao sistema de transpor te público da cidade começou a ser feito no mês de junho no muni cípio londr inense
O o b j e t ivo é q u e ve í c u l o s c o m essa tecnolog ia mais sustentável sejam i n c o r p o r a d o s à f ro t a d e t r a n s p o r t e c o l e t ivo, c o n t r i bu i n d o p a r a u m a c i dade mais limpa e inteligente O veí culo a gás em demonstração é o mes mo que já circulou pelas r uas de Cu r i t i b a e re g i ã o m e t ro p o l i t a n a E m L o n d r i n a , e l e s e r á a b a s t e c i d o c o m o b i o m e t a n o, p ro d u z i d o a p a r t i r d e subprodutos do setor sucroe nergéti
co, e revendido pela Gastech que co mercializa o GNV em Londr ina
O modelo f abr icado pela Scania é o padron K 280, com 14 metros de compr imento e capacidade para 86 passageiros Tem propulsor de 280 ca valos de potência Seu motor é Ciclo Otto (o mesmo conc eito dos auto móveis) e movido 100% a gás e bio metano, ou mistura de ambos Para o ônibus em teste, foram instalados oito cilindros de gás na lateral di anteira com uma autonomia de 300 km
A A s s o c i a ç ã o B r a s i l e i r a d a s E m p re s a s D i s t r i bu i d o r a s d e G á s C a n a l i z a d o ( A b e g á s ) e n xe r g a e s s a i n i c i a t iva c o m o u m p a s s o re l eva n t e p a r a q u e o B r a s i l p ro m ova p o l í t i c a s p ú bl i c a s q u e a m p l i e m a p a r t i c i p a ç ã o d o g á s c a n a l i z a d o e m ve í c u l o s d e t r a n s p o r t e d e p a s s a g e i ro s e c a r g a , c o m o
ô n i b u s e c a m i n h õ e s , n a m a t r i z d e t r a n s p o r t e d o p a í s
O gás natural é uma fonte de energ ia mais limpa em comparação a outras fontes de or igem fóssil, contr i
A venda do pr imeiro trator movi do a biometano no Brasil inaugura um novo segmento de máquinas ag rícolas e marca o início de uma nova etapa na busca pela transição energética no país
O modelo T6 180 Methane Power, da New Holland, com motor da FPT In dustr ial, que utiliza gás proveniente da decomposição de resíduos orgânicos como combustível foi adquir ido pela SF Ag ropecuár ia, uma empresa sedia da em Brasilândia MS e atuante no setor de suinocultura, com um abate anual de cerca de 180 mil animais

O trator, impor tado de B asildon, possui um motor N67 NG de 180 cv de potência e 740 Nm de torque, o
modelo entrega o mesmo desempe nho e durabilidade de um equivalen te diesel Em condições reais de tra balho, as emissões são reduzidas em até 80% em comparação a um trator convencional, oferecendo inúmeras vantagens ambientais, com custos d e operação até 30% mais baixos e me nor vibração
Para a SF Ag ropecuár ia, a aquisição do trator representa benefícios ambien tais e operacionais em suas fazendas, que além da produção suína, também pos suem um rebanho de 33 mil bovinos e uma área de plantio com futura produ ção de 1,6 mil hectares de soja e outros mil hectares de sorgo O trator movido a biometano oferece uma fonte de
E m c o m p a r a ç ã o c o m o d i e s e l , ve í c u l o s e s p e c i a l m e n t e p ro j e t a d o s p a r a u t i l i z a r g á s n a t u r a l p ro p o rc i o n a m u m a re d u ç ã o d e 2 3 % n a s e m i s s õ e s d e C O 2 ( g á s c a u s a d o r d o e f e i t o e s t u f a ) , u m a d i m i nu i ç ã o d e 9 0 % n a e m i s s ã o d e N O x ( g a s e s p re j u d i c i a i s à camada de ozônio) e uma redução de 8 5 % n a l i b e r a ç ã o d e m a t e r i a l p a r t i c u l a d o ( o p r i n c i p a l c o m p o n e n t e d a f u m a ç a p re t a )
Os benefícios sociais também são evidentes Uma pesquisa realizada pe lo Instituto Saúde e Sustentabilidade em 2019 mostrou que a implementa ção do GNV (Gás N atural Veicular) no transpor te público resulta na dimi nuição da emissão de poluentes, o que pode ter um impacto positivo na saú de pública, além de trazer ganhos de produtividade e economia nos gastos públicos relacionados à saúde
energ ia limpa e renovável, com uma produção de CO2 significativamente menor do que outras opções
A disponibilidade do combustível no local também é uma g rande van tagem para a f azenda, como enf atiza Fábio Pimentel de Bar ros, diretor da SF Ag ropecuár ia
Além de utilizar o biometano como combustível para o trator, a empresa também aproveita o gás produzido em suas fazendas para a geração de eletr ici dade e abastecimento de um caminhão Bar ros destaca que, em ter mos de eco nomia, o uso do gás como substituto do diesel é três vezes mais vantajoso do que a geração de eletr icidade a partir dele Antes de ser comercializado no Brasil, o trator passou por testes desde 2017 como protótipo, com resultados excelentes Em 2022, o modelo T6 Methane Power foi eleito Trator Sus tentável do Ano durante a EIMA In ter nacional, uma impor tante feira mundial de máquinas ag rícolas, reali zada em Bolonha, na Itália
Transpor te coletivo será abastecido com gás produzido a par tir de subprodutos do setor sucroenergético
A planta de biogás da Cocal aca ba de receber a cer tificação do Reno vaBio pela produção sustentável de biometano a par tir do processamento de resíduos da cana de açúcar e de atividades ag ropecuár ias (orgânicos ag rossilvopastor is)
Dessa for ma, se tor nou a pr imei ra usina da categor ia a ser cer tificada no RenovaBio, segundo reg istros da ANP (Agência Nacional do Petróleo, Gás Natural e Biocombustíveis)
O processo de cer tificação teve início em fevereiro desse ano, a par tir de uma auditor ia exter na realizada pela empresa Benr i, em que analisa ram o processo de produção do bio metano na planta da Cocal
“É um marco para a Cocal e bus caremos sempre a melhor ia em pro
cessos da nossa usina Vamos nos tor nar cada vez mais sustentáveis e, com isso, reforçar nossa nota de eficiência energética ambiental, trazendo resul tados para a nossa companhia”, disse Felipe Kur ihara, analista de novos produtos da Cocal, que acompanhou o processo de cer tificação
Com validade de um ano, a cer ti ficação per mite à empresa emitir os créditos de descarbonização (CBIOs),
com base na sua produção de biome tano – capacidade de até 25 mil m³/dia na planta de Narandiba

“O RenovaBio é de extrema im por tância para o Brasil, tanto do pon to de vista ambiental quanto econô mico, e foi cr iado com o objetivo de promover a expansão do uso de bio combustíveis na matr iz energética brasileira, visando a redução das emis sões de gases de efeito estuf a e o cum
pr imento das metas do Acordo de Pa r is Para a Cocal não é diferente e é por isso que hoje temos os cer tifica dos no etanol e no biometano Será pr imeira empresa a obter o cer tifica do de biometano, or iundo de resíduos ag rosilvopastor is, é uma g rande hon ra, um marco para o setor e vai ao en contro das nossas metas estratég icas”, explica Jonatan Vieira, super visor co mercial e de novos produtos da Cocal

Será primeira empresa a obter o cer tificado de biometano, oriundo de resíduos
O D e p a r t a m e n t o d e I n f r a e s t r u t u r a d a Fe d e r a ç ã o d a s I n d ú s t r i a s d o E s t a d o d e S ã o Pa u l o ( F i e s p ) v ê n o biometano um caminho de op or tu n i d a d e s p a r a a d e s c a r b o n i z a ç ã o d a s indústr ias
Para dar a dimensão do potencial do biogás, as 311 milhões de tonela das de cana moída no estado de São Paulo (safra 2022/23) podem se con ver ter em um total entre 42 mi lhões de m3/dia e 50 milhões de m3/dia de biogás e entre 20 milhões de m3/dia a 35 milhões de m3/dia de biometano
E ainda há espaço para ganhos de produtividade de conve r são com as novas tecnolog ias de equipamentos
O p o t e n c i a l d e p ro d u ç ã o e s t á concentrado nas áreas Nor te e Oes t e d o e s t a d o, e n q u a n t o a d e m a n d a p o t e n c i a l , p e l a s i n d ú s t r i a s p e t ro q u í mica, química, fer tilizante, vidro, ci m e n t o, c e r â m i c a , m e t a l u r g i a / s i d e r urg ia, têxtil e celulose, se encontra a L e s t e d o e s t a d o Po r t a n t o, é p re c i s o alinhar ofer ta e demand a, o q ue im p l i c a t a m b é m i nve s t i m e n t o n o s e t o r de infraestr utura, superando esse des casamento espacial
Estudo da F iesp indica que são necessár ios 1 213 km de gasodutos para conectar os pr incipais pontos potenciais de biogás às redes de distr i buição mais próximas, com investi mento estimado de R$ 2,3 bilhões O estudo aponta a existência de com plexidades regulatór ias cujo arcabou ço precisa de ajuste

Com infraestr utura de conexão, regulação adequada e linhas apropr ia das de financiamento verde – com prazo e juros adequados – será possí vel viabilizar projetos de biometano com preços competitivos para a in dústr ia Vale ressaltar ainda que se tra ta de energ ia renovável
Ele pede atenção à velocidade de adaptação, pois é mais rápido constr uir uma planta produtora de biometano do que um gasoduto Outro f ator apontado, em ter mos de política pú
blica, é que o biometano pode ter seu volume adensado com a inclusão d e ater ros sanitár ios
Segundo a Associação Brasileira do Biogás (Abiogás), atualmente existem 811 plantas de biogás, 755 delas em operação, 102 novas desde 2021 e, em São Paulo, 46 plantas com produção de 1,7 milhão de m3 dia que f azem o aproveitamento econômico e produção crescente de biometano Até 2029, há a previsão de entrada em funcionamen
to de mais 21 novas usinas de biome tano no estado, concentradas em Pau línia, Piracicaba, Caieiras, Guar ulhos, Olímpia,Várzea Paulista e Elias Fausto
Com potencial de quase 200 mil m3 dia, nos próximos anos poderá al cançar 2 milhões de m3 dia A de manda de investimentos para a infra estr utura de escoamento é da ordem de R$ 2 bilhões
Em recente reunião do Conselho Super ior de Desenvolvimento Sus
tentável (Condes) da Fiesp,o secretá r io executivo do Ministér io do Meio Ambiente e Mudanças do Clima, João Paulo Capobianco destacou a impor tância da par ticipação das indústr ias “O enfrentamento à mudança do c l i m a é u m d o s m a i o re s d e s a f i o s d a humanidade”, disse Capobianco, pa ra quem a indústr ia é um impor tan te player neste cenár io e a interlocu ç ã o e n t re g ove r n o e s e t o r e m p re s a r ial, essencial

Fabio Barbosa, presidente do Condes, lembrou que hoje o sistema financeiro tem compromiss o com o por tfólio de sustentabilidade, especial mente com o escopo 3, ou se ja, as emissões pelas quais a empresa é indi retamente responsável
“A questão da sustentabilidade é transver sal” disse, e como “existem muitas restr ições também existem muitas opor tunidades”, completou, ao tratar do engajamento da indústr ia no tema e o necessár io financiamento para se realizar a transição energética
Nessa agenda, a Abiogás defende for te estr utura de cer tificação, simpli ficação do licenciamento ambiental, estabelecimento de cor redores sus tentáveis, uso do biometano no trans por te público e pr ivado, marco regu latór io, aperfeiçoamento do prog rama Paulista do biogás e atenção às cargas tr ibutár ias tanto na produção como no consumo
O biometano gerado pelas usinas de cana possibilita a conexão das áreas com demanda às produtoras
O engenheiro Industr ial Quími co, com 36 anos de exper iência e Mestrado em Biocombustíveis, Fer nando Cesar Calsoni, decidiu através da publicação do livro “Etanol de biomassa de milho, utilização de aprendizagem de máquina no estudo de casos de caldeiras”, compar tilhar um pouco dessa vivência na produção do etanol a par tir do milho

Segundo Calsoni, o etanol or iun do da cana de açúcar, conta com uma g rande gama de estudos, já no caso do milho, no Brasil, o estudo ain da é embr ionár io, pr incipalmente no que se refere às caldeiras
“O livro trata de um equipamen
to de extrema impor tância, que são as caldeiras, dentro de qualquer unidade f abr il especialmente as bior refina r ias Procurei abordar de maneira am pla, alguns conceitos gerais referentes às biomassas: cana de açúcar e milho, bem como a utilização de uma cal deira dentro do contexto de uma uni dade " full" milho Já que não é tão
dominante a produção de bioener g ia no Brasil com o milho vem cres cendo de for ma exponencial como é o caso, de caldeiras operan do dentro de bior refi nar ias na produção de etanol, açúcar, bioprodutos e b i o e l e t r i c i d a d e or ig inár ia da cana de açúcar”, explica Calsoni Para simular o compor tamento das ca deiras, o autor se utiliza de conceitos da AI (Inteligência Ar tificial) e ML (Apren dizado de Máquinas) –“muito em fo co na mídia atualmente, possível de ser aplicado em diver sos setores da socie dade , buscando a explicação real , da teor ia para a prática e vice ver sa, por nós vivenciada em diver sas opor tunidades”, sublinha Calsoni

A ideia de escrever o livro surg iu após Calsoni receber um convite e ser incentivado por colegas e professores da UFU (Univer sidade Federal de Uberlândia/MG), onde fez seu Mes
trado na área de Bioenerg ia (Ciências dos Biocombustíveis)
“Com minha exper iência de cer ca de 36 anos, passando por vár ias empresas sucroenergéticas, projetos, papel e celulose, química, na produção de bioenerg ia de pr imeira geração (etanol de cana e milho), segunda ge ração (etanol celulósico), este projeto literár io veio como uma opor tunida de de deixar uma modesta contr ibui ção para o setor”, relata Calsoni N o l iv ro, o a u t o r a f i r m a q u e p ro c u ro u a g r u p a r e c o n d e n s a r, n ã o s ó u m a p e s q u i s a c i e n t í f i c a ( d i s s e r t a ç ã o ) , m a s s i m u m a e x p e r i ê n c i a p r ó p r i a d e c a m p o, e s c reve n d o a q u i l o q u e mu i t o s p ro f i s s i o n a i s bu s c a m , p e r g u n t a m e g o st a r i a m d e s a b e r c o m u m p o u c o m a i s d e d e t a l h e s “ O a s s u n t o é mu i t o a m p l o, p ro f u n d o e f a s c i n a n t e, e n ã o f o i m i n h a i n t e n ç ã o e s g o t á l o, m a s s i m p ro c u r a r d e s p e r t a r o u t ro s a m i g o s e c o l e g a s , p a r a t r a duzir, nos escr itos suas exper iências”, a f i r m a o e s c r i t o r Lançado pela Editora Dialética, o livro também pode ser encontrado na ver são dig ital

“Etanol de biomassa de milho, utilização de aprendizagem de máquina no estudo de casos de caldeiras” é o título da obra escrita por Fernando Cesar Calsoni


Preto - SP
A Ag r ishow 2023 – 28ª Feira In ter nacional de Tecnolog ia Ag rícola em Ação, realizada entre os dias 1º e 5 de maio, em Ribeirão Preto
SP, alcan çou um volume recorde de R$ 13,290 bilhões de negócios gerados e inten ções de compra em máquinas ag ríco las, de ir r igação e de ar mazenagem
Esse montante representa um crescimento nominal de 18% e um aumento real de 9,5% (descontada a inflação) em relação à edição de 2022, quando foram computados R$ 11,243 bilhões de negócios gerados e inten ções de compra de máquinas ag ríco las, de ir r igação e de ar mazenagem
Em ter mos de visitação, a Ag r is how 2023 rece beu um total de 195 mil pessoas, em sua maior ia, produto res r urais de pequenas, médias e g ran des propr iedades de todas as reg iões do país e também do exter ior
Para João Carlos Marchesan, vice presidente do Conselho de Administra ção da Associação Brasileira da Indústr ia de Máquinas e Equipamentos (ABI
MAQ) e novo presidente da Agr ishow, “ a feira cresce fortemente a cada ano e apresenta máquinas, tecnologias e solu ções para todos os tamanhos de pro pr iedade rural e para os var iados tipos de cultura, atendendo as pr incipais deman das para o produtor rural crescer ”
A feira é organiz ada pela Abag
Associação Brasileira do Ag ronegócio, Abimaq – Associação Brasileira da In dústr ia de Máquinas e Equipamentos, Anda – Associação Nacional para Di fusão de Adubos, Faesp – Federação da Ag r icultura e da Pecuár ia do Estado de São Paulo e SRB – Sociedade Ru ral Brasileira A próxima edição da Ag r ishow será realizada entre os dias 29 de abr il e 3 de maio de 2024
A Secretar ia de Ag r icultu r a e A b a s t e c i m e n t o d o E s t a d o de São Paulo promoveu no dia 3 de maio, durante a Ag r ishow, a a p re s e n t a ç ã o d o s n ú m e ro s l eva n t a d o s p e l o ‘ E t a n o l M a i s Ve rd e ’ , s a f r a 2 0 2 2 / 2 3 Pa r a o eve n t o re a l i z a d o n o a u d i t ó r i o do IAC, Centro de Cana, esta va m p re s e n t e s o s e c re t á r i o e xe c u t ivo d a p a s t a , M a rc o s R e n a t o B ö t t c h e r e re p re s e n tantes dos signatár ios do pro t o c o l o, p o r p a r t e d a s u s i n a s e associações
O prog rama tem como objetivo estimular as melhores práticas ag roambientais e a sus tentabilidade da cadeia produ tiva da cana de açúcar Além disso, sua finalidade é também solucionar os desafios comuns do setor sucroenergético, bus cando avanços na área ambien tal, social e econômico em to do o Estado de São Paulo
Os resultados extraordinár ios no campo, devido às boas condições cli máticas, têm refletido em novos inves timentos dos produtores de cana de açúcar, como é o caso de José Maurí cio de Alburquerque Tavares, da Fazen da Per i per i, localizada em Teotonio Vilela, AL, que visitou a feira em busca de novidades
Tavares é de uma família que planta cana há quatro gerações Atualmente, tem uma produção de 60 mil tonela das de cana que for nece para a Usina Impacto Bioenerg ia, localizada também no município de Teotonio Vilela
“Sempre visitamos a feira para acompanhar as novidades tecnológ icas voltadas para a ag r icultura, pecuár ia Nos interessa essa par te de colheita mecanizada, plantadeira, o conjunto completo”, disse, que contou ter ter
minado a safra em abr il, com sucesso “Foi uma ótima safra Com precipita ção boa, muita umidade que elevou a produtividade No meu caso, chegou
per to de 100 toneladas por hectares, o que é considerado extraordinár io Um ganho significativo, para produtor de cana comemorar ” , finalizou
B ö t t c h e r s e m o s t ro u b a s tante otimista com a continui d a d e d o ‘ E t a n o l M a i s Ve rd e ’ e p ro j e t o u u m c re s c i m e n t o n a re g u l a r i z a ç ã o a m b i e n t a l e m S ã o Pa u l o. “ A m e t a d e f i n i d a p e l o s e c re t á r i o A n t o n i o Ju n q u e i r a é q u e a re g u l a r i z a ç ã o a m b i e n t a l a l c a n c e 1 0 0 % n o E s t a d o d e S ã o Pa u l o E s t a m o s o t i m i s t a s e va m o s t r a b a l h a r for te para alcançar esse objeti vo ” , disse
D e s d e o i n í c i o d o p ro t o c o l o, h o u ve e l i m i n a ç ã o d a queimada e deixaram de emi t i r 7 2 , 4 m i l h õ e s d e t o n e l a d a s d e p o l u e n t e s a t m o s f é r i c o s (monóxido de carbono, mate r ial par ticulado e hidrocarbo netos) e 12,04 milhões de to neladas de gases de efeito estu f a (GEE)
A área restaurada cumula tiva estimada desde o início do p ro t o c o l o é d e 3 0 m i l h e c t a re s , c o m m a i s d e 5 0 m i l h õ e s d e mu d a s d e á r vo re s n a t iva s p l a n t a d a s
aconteceu no período de 1º a 5 de maio, em Ribeirão
U m d o s b e n e f i c i a d o s p e lo co nvê n i o co m o
I AC d e S P, a g r i c u l to r u t i l i z a e s t a n d e d a p a s t a n a Ag r i s h ow p a ra a t ra i r c l i e n te s
A f amília do ag r icultor Renato Trevizoli está no ramo da cana de açúcar há qu atro gerações Ele conta que a “virada de chave” na trajetór ia de mais de meio século do negócio iniciado pelo bisavô se deu a par tir de 2015, ao fir mar parcer ia com o Insti tuto Ag ronômico (IAC)
A f azenda de Trevizoli fica em Ta quar itinga – SP A produtividade da la voura foi impulsionada com o plantio de mudas pré brotadas (MPB) a par tir do mater ial genético produzido pe lo IAC, por meio do Prog rama Cana
“O mater ial sai do IAC com ates tados de sanidade e de or igem genéti ca, cumpr indo todos os cr itér ios para a gente levar a propagação à frente Nós pegamos essa muda e plantamos lá na fazenda Dessa plantação, tiramos o mi ni rebolo, que é a ‘geminha’, e produ zimos as mudas pré brotadas”, conta o produtor A par tir disso, as mudas de cana são vendidas para usinas, associa
ções e produtores independentes
Ele explica que, para fir mar o convênio, teve que atender a uma sé r ie de exigências de qualidade e sus tentabilidade por meio de cer tificações inter nacionais
“Essa parcer ia com o IAC não cai do céu Nós passamos por um cr ivo, com padrões de qualidade, para que nos confiassem a responsabilidade de propagar o mater ial genético que eles desenvolvem A patente, o ‘filho’, é deles Eles nos dão a opor tunidade de propagar esse mater ial e entregar para o setor sucroenergético”
O produtor de cana explica que a parcer ia potencializa os negócios no se tor Além do selo de qualidade do IAC, o acordo de cooperação técnica possibilita o cultivo de var iedades que se adaptam melhor às condições da fazenda
“Foi uma virada de chave A par tir do momento que obtivemos aces so a essa tecnolog ia, ganhamos a opor tunidade de ter um leque de va r iedades à disposição, cada uma com um nicho específi co para expr imir o potencial genético Quando temos opções de mater iais dentro da pro pr iedade, conseguimos identificar qual deles se adapta melhor à nossa condi ção de solo e manejo”, afir ma
A empresa de Trevizoli foi uma das participantes no estande da Secretar ia de Agr icultura e Abastecimento na Agr is how Ali foram apresentadas as tecnolo gias e inovações desenvolvidas pelos seis institutos ligados à Agência Paulista de Tecnologias do Agronegócios
Além de expor tecnolog ia a novas técnicas a potenciais clientes, o produtor ressalta que a participação na feira tam bém serviu como vitr ine daquilo que considera o diferencial da Agrícola Tre

vizoli: a assistência técnica pós venda.
“ A g e n t e ve n d e e t a m b é m e n s i n a c o m o p l a n t a r e c u i d a r, q u a l é o m e l h o r l o c a l p a r a a l o c a r ( a p ro d u ç ã o ) D a m o s s u p o r t e p a r a f a z e r o n e g ó c i o d a r c e r t o, n ã o é s i m p l e s m e n t e ve n d e r A A g r i s h ow t e m u m a v i s i b i l i d a d e e n o r m e O a g ro n e g ó c i o p a s s a p o r a q u i , e n t ã o t e m o s a e s p e r a n ç a d e a t i n g i r m a i s c l i e n t e s , m a i s p ro d u t o re s e m o s t r a r n o s s o d i f e re n c i a l ” , re s s a l t a
Daniel Nunes, engenheiro ag rô nomo, da equipe do prog rama de melhoramento do IAC, infor mou que, na feira, foram expostas as pr incipais cultivares de cana do instituto que es tão sendo adotadas pelo mercado e também os últimos dois lançamentos, realizados em 2021 e 2022
Além das for mas de multiplicação, como a MPB, foram apresentadas ou tras tecnolog ias desenvolvidas dentro do IAC, entre elas a Invicta
A tecnolog ia de produção d e “muda semente de cana ” fundamen ta se na limpeza clonal de var iedades de cana, em laboratór ios de cultura de mer istemas, seguida da checagem da sanidade, utilizando métodos avança dos de bi olog ia molecular, além da identidade genética cer tificada por finger pr int de DNA
Os resultados evidenciam que é possível elevar a produtividade (até 250 t/ha) e longevidade dos canaviais (até 12 anos), a patamares estes ainda não alcançados no setor

Nos pr imeiros meses deste ano, de janeiro a abr il, a ofer ta de energ ia elé tr ica para a rede a par tir da biomassa da cana de açúcar foi de 1 858 699 MWh, segundo levantamento da União da Indústr ia de Cana de Açúcar e Bioenerg ia (UNICA)
"Essa geração renovável é equiva lente a atender ao consumo anual de energ ia elétr ica de quase três milhões de pessoas ou a 8% da geração tér mi ca a gás no país em 2022”, compara o gerente de Bioeletr icidade da organi zação, Zilmar Souza
E m t e r m o s p e rc e n t u a i s , t r a t a s e d e u m a u m e n t o d e 2 8 , 7 % e m re l a ç ã o a o m e s m o p e r í o d o d o a n o p a s s a d o, q u a n d o f o i o f e r t a d o 1 4 4 3 9 5 4 M W h p a r a a re d e “ É u m a u m e n t o b a s t a n t e c o n s i d e r á ve l , e s p e c i a l m e n t e s e l eva r m o s e m c o n t a q u e n e s s e p e r í o d o e s t á va m o s p r a t i c a m e n t e n a e n t re s s a f r a d a c a n a ” , c o m e n t a o g e re n t e d a U n i c a
Zilmar Souza explica que, com o início oficial da safra sucroenergética na reg ião Centro Sul em abr il, a bio
eletr icidade para a rede, envolvendo todas as biomassas, representou 3,7% da geração total no país naquele mês, ocupando a terceira posição em ter mos de representatividade Esse per centual supera a geração fotovoltaica e a geração tér mica a gás Já em maio, representou 6,2% da geração total no país No acumulado de janeiro a maio, o indicador da bioeletr icidade em ge ral foi de 3% na geração total no país
A geração de bioeletr icidade no Brasil remonta à década de 1980, quando teve início em usinas da re g ião metropolitana de Ribeirão Preto (SP) Em 1987, a São Francisco, do Gr upo Balbo e associada à Unica, foi a pr imeira a expor tar energ ia elétr ica obtida de uma fonte 100% renovável para a CPFL Energ ia Na sequência, a São Mar tinho, de Pradópolis (SP), e a Vale do Rosár io, em Mor ro Agudo (SP), iniciaram seus projetos de gera ção de bioeletr icidade
Atualmente, cinco estados brasi leiros detêm 89% da capacidade ins talada pela bioeletr icidade sucroener gética São Paulo li dera o ranking, com 208 usinas ter melétr icas (UTEs), representando 50% da capacidade ins talada Em seguida vem Minas Gerais (13%), com 48 UTEs; Goiás (12%), com 35 UTEs; Mato Grosso do Sul (9%), com 24 UTES; e Paraná (5%),
com 29 UTEs. No total, são 422 usi nas ter melétr icas que utilizam o ba gaço e a palha da cana de açúcar
A biomassa de cana de açúcar representa 72% de toda a capacidade instalada de bioeletr icidade no Brasil
em São Paulo, esse percentual é de 90,5% Trata se da quar ta fonte mais impor tante na matr iz elétr ica brasilei ra, com 6,3% da capacidade instalada no país Se forem consideradas todas as biomassas, a capacidade instalada to taliza 17 082 MW, representando 8,8% da potência instalada na matr iz elétr i ca do Brasil
Segundo o levantamento da Uni ca, nos últimos 10 anos, de 2013 a 2022, a fonte biomassa acrescentou 6 914 MW novos à matr iz elétr ica brasileira, equivalente a quase metade da potência instalada pela usina Itaipu, hidrelétr ica que em 2022 gerou o equivalente a 13,7% do consumo d e energ ia elétr ica no Brasil

Z i l m a r S o u z a re s s a l t a q u e a b i o e l e t r i c i d a d e o f e r t a d a p e l o s e t o r s u c ro e n e r g é t i c o é s e m p re u m a g e r a ç ã o e s t r a t é g i c a p a r a o p a í s E l e e xe m p l i f i c a c o m o a n o d e 2 0 2 1 , q u a n d o o B r a s i l p a s s o u p e l a p i o r c r i s e h i d ro l ó g i c a n o s e t o r e l é t r i c o b r a s i l e i ro d e s d e a d é c a d a d e 1 9 3 0 N a q u e l e a n o, a e n e r g i a d a b i o m a s s a d a c a n a p o u p o u 1 4 % d a c a p a c i d a d e t o t a l d e
s e a r m a z e n a r e n e r g i a s o b a f o r m a d e á g u a n o s re s e r va t ó r i o s d a s h i d re l é t r i c a s d o s u b m e rc a d o S u d e s t e / C e n t ro O e s t e, p o r c o n t a d a m a i o r p re v i s i b i l i d a d e e d i s p o n i b i l i d a d e d a b i o e l e t r i c i d a d e n o p e r í o d o s e c o e c r í t i c o p a r a o s e t o r
Em comparação com energ ia de or igem fóssil, a bioeletr icidade da ca na é uma solução muito mais susten tável “É uma fonte de energ ia susten tável, pois é gerada a par tir de maté r ia orgânica de or igem vegetal, o que f az com o gás carbônico emitido por ela seja absor vido pelas plantas, dife rentemente de como ocor re com uma fonte fóssil”, explica Zilmar Souza E l e d e t a l h a q u e a b i o e l e t r i c i d a d e g e r a d a p e l o s e t o r, s o m e n t e e m 2 0 2 2 , ev i t o u a s e m i s s õ e s d e g á s c a r b ô n i c o e m q u a s e q u a t ro m i l h õ e s d e t o n e l a d a s , e m va l o re s e s t i m a d o s , m a rc a q u e s o m e n t e s e r i a a t i n g i d a c o m o c u l t i vo d e 2 7 m i l h õ e s d e á r vo re s n a t iva s p o r 2 0 a n o s Ambientalmente, mesmo em comparação com outras culturas do campo, a cana se destaca Após a co lheita, a palha fica no solo, oferecen do proteção natural contra a erosão e er vas daninhas, reduzindo a ne cessi dade de defensivos ag rícolas Outro subproduto do canavial, a vinhaça, é utilizado como fer tilizante natural, além de também se poder gerar ener g ia elétr ica por meio do biogás
Ofer ta foi equivalente a atender o consumo anual de energia elétrica de quase três milhões de pessoas

Com 84% de chance de intensida de moderada e 56% de chance de in tensidade for te, a ação do fenômeno climático El Niño, que segundo a Ad ministração Oceânica e Atmosfér ica Nacional dos Estados Unidos (NOAA), já atua sob o clima, podem alterar as estimativas promissoras de recuperação apontadas no início da safra
O El Niño tem a característica de intensificar os sistemas meteorológ i cos, com ampliação das chuvas no sul do Brasil Segundo o Climatempo, a condição mais chuvosa deve ocor rer em áreas entre São Pa ulo e Mat o Grosso do Sul, algumas das pr incipais áreas produtoras de cana de açúcar do Centro Sul, no início da pr ima vera isso deve impactar o período fi nal de cor te e moagem
No acumulado da safra 2023/24, iniciada em abr il, a moagem de cana do Centro Sul ating iu 125,38 mi lhões de toneladas, um avanço de 16,76% ante igual período da tempo rada passada, confor me dados da União da Indústr ia de Cana de Açúcar e Bioenerg ia (UNICA)
“Se a expectativa de superar a marca de 600 milhões vier a se con cretizar, é necessár io que tal def asagem seja compensada, seja por um bom r itmo de colheita nos meses mais se cos – que tem sido colocado em xe
que pelo advento do El Niño – seja por um prolongamento da safra que até o mês de d ezembro de 2023, ou antecipação do início do ciclo seguin te para março de 2024”, aler tou a en tidade que representa as usinas
Para o analista de mercado da StoneX, Marcelo Filho, é a intensida de do El Niño quem deve ditar o de sempenho da safra “Estamos vendo um começo de safra excelente, com usinas produzindo o máximo de açú car que podem porque é o que o mercado está pagando melhor, mas o
setor está preocupado Se o El Niño vier muito for te – e as probabilidades disso estão aumentando
o impacto ser ia maior”, acrescentou. Atualmente, a StoneX prevê moagem de 595,9 milhões de tonela das para o Centro Sul na safra 2023/24, um incremento de 8,7% em relação ao ciclo anter ior Este avanço per mitir ia uma elevação de 10,2% na produção de açúcar, para 37,2 milhões de toneladas
A DATAGRO também afir ma que as condições climáticas estão ca da vez mais f avoráveis ao El Niño, sendo que a pr imeira estação a ser in fluenciada pelo fenômeno é o inver no, que começou no dia 21 de junho De acordo com a consultor ia, a Temperatura da Superfície do Mar (TSM) vem se mostrando f avorável desde maio” e, em média, as reg iões de cana de açúcar e café do Sudeste deverão ter um clima entre 0,5 e 2ºC mais quente

Já a análise mostra que, no Sul do país, as áreas produtoras de g rãos de verão reg istrar temperaturas acima da média histór ica, mas episódios de gea das não estão descar tados para os pró ximos meses
O maior volume de produção de açúcar vai depender do clima de agora em diante
“As usinas do Centro Sul do Brasil estão maximizando a alocação de cana para produção de açúcar o quando podem; e isso não é novidade para ninguém acompanhando a par i dade de preços entre açúcar e etanol
No entanto, o que é impressionante é o patamar de mix que as usinas con seguiram ating ir na última quinzena
O mix de açúcar acumulado até o fi nal de maio ating iu 46 9%, o maior desde 2006”, afir ma Ana Zancaner, analista da Czar nikow, trading br itâ nica de alimentos e ser viços

Segundo ela, até agora, os números quinzenais de produção estão em linha com as estimativas da trading, por tanto eles mantêm a projeção para produção de açúcar em 37,7mi toneladas
“Mas como o mix de açúcar ul trapassou o que era esperado, nos per
guntamos se o máx açúcar ser ia maior que 47,5% Pode ser, mas o quão maior vai depender das condições cli máticas O impacto do El Niño no CS não é totalmente definido, mas pode trazer mais chuvas”, explica Ana No último mês, o diferencial físico para o açúcar br uto VHP (FOB Santos) caiu significativamente – indo de uma média de 46 pontos em maio para 0 essa semana Geralmente é a dinâmica do mercado A safra avança, mais açú car disponível resulta em um desconto
no açúcar contra os preços da tela
“No entanto, não é o que se es pera de uma safra com competição logística acir rada Como explicamos em nosso relatór io da semana passada, esse mês as coisas parecem calmas an tes do fluxo das expor tações de mi lho”, elucida
Apesar da longa fila de navios, com tempo de espera para atracar por vol ta de 13 dia s em Santos, a demanda deu uma esfr iada por conta dos pre ços altos Essa f alta de liquidez no
mercado físico impactou o compor tamento do diferencial físico nas últi mas semanas “Acreditamos que o diferencial fí sico (FOB Santos) deve voltar a subir uma vez que o fluxo de descida do açúcar para Santos ficar mais difícil Imag ina, um vendedor tem um navio para car regar e não tem açúcar sufi ciente disponível no ter minal A esco lha é: paga conta de demur rage ou compra açúcar FOB spot Quem tiver açúcar no por to pronto deve se bene ficiar e vender a um preço maior”, afir ma a analista
De acordo com ela, o diferencial físico FCA (Free Car r ier) por outro lado deve despencar Nor malmente FCA já é mais barato que o FOB por não ter os custos logísticos incluídos
“No entanto, esperamos que caiam ainda mais nesta safra Se a produção de açúcar for de f ato maior que o espe rado, esse açúcar adicional não terá lo gística contratada requerendo um des conto ainda maior A safra mal come çou e já mostra algumas dinâmicas in teressantes ” , conclui a analista


A média dos últimos anos do agricultor chegou a no máximo 100 TCH e com a mudança no manejo a produção atingiu 113 TCH
Há mais de 50 anos no setor su croenergético, produtor da reg ião de Piracicaba/SP, conhecida por seus so los arenosos de classificação D e E, e nos últimos anos com baixo índice pluviométr ico, alcançou resultados expressivos após adotar a adubação biológ ica como manejo padrão em suas propr iedades O produtor, que for nece matér ia pr ima para um g rande g r upo de usinas, estava prestes a trocar de reg ião devido aos resulta dos insatisf atór ios obtidos nessas pro pr iedades de solos restr itivos No en tanto, após incluir o Adubo Biológ i co produzido com Microgeo® em seu manejo padrão, não apenas decidiu per manecer na reg ião, como ampliou a adoção do manejo biológ ico para 100% da área plantada
O M i c rog e o ® é u m c o m p o n e n t e b a l a n c e a d o q u e nu t re, re g u l a e m a n t é m a p ro d u ç ã o c o n t í nu a d o A d u b o B i o l ó g i c o p o r m e i o d o P ro c e s s o d e C o m p o s t a g e m L í q u i d a C o n t í nu a ( C L C ) E s s a s o l u ç ã o i n ova d o r a é a ú n i c a q u e m a n e j a e re s t a b e l e c e o
m i c ro b i o m a d o s o l o a t r av é s d o a u m e n t o d a d ive r s i d a d e b i o l ó g i c a , q u e p o s s u i e m m é d i a 5 0 0 g r u p o s d i f e re n t e s d e m i c ro r g a n i s m o s c o m d i f e re n t e s f u n ç õ e s
Com uma área cultivada de 13 mil hectares de cana de açúcar, o pro dutor Odair Novello realiza anual mente a refor ma de cerca de 1 200 hectares, onde também cultiva soja A introdução da Biotecnolog ia Micro geo® ocor reu em 2020, inicialmente na cultura da soja, e em 2022 foi es tendida para a cana de açúcar, que de imediato já trouxe resultados posi tivos “É difícil competir com outras reg iões que têm solos com classifica ção A, B e C É um desafio muito g rande para nós”, disse Renan Alecio, Gerente Ag rícola

As avaliações de campo realizadas ao longo do desenvolvimento vegeta tivo da cana, como de enraizamento e as biometr ias, já demonstraram ganhos significativos da área com aplicação do Adubo Biológ ico Desde o início do ciclo, mesmo os resultados visuais na



Biometria de raiz realizada em 13/12/2022. Área testemunha com 14,64% e área com aplicação da Biotecnologia Microgeo® com 32,66%
área tratada com a Biotecnolog ia Mi crogeo® já foram impressionantes A biometr ia de raiz, por exemplo, com provou os 44% de aumento do siste ma radicular
Alecio expressou sua satisf ação com os resultados obtidos: "Estamos vindo de 2, 3 anos com clima muito r uim e mesmo assim a tecnolog ia perfor mou bem Hoje, f aço aplicação
em 100% da área plantada, tanto via solo como via pulver ização", contou Ele ressaltou que a reg ião enfrenta de safios significativos devido aos solos arenosos e ao baixo índice pluviomé tr ico dos últimos anos No início do último ciclo da cultura, os pr imeiros 150 dias recebeu apenas 68 mm de chuva, impactando o desenvolvimen to vegetativo
O Gerente mencionou que co nheceu a Microgeo há sete anos, mas inicialmente teve receio de utilizá la por ser uma tecnolog ia nova na reg ião No entanto, após tomar conhecimen to de resultados positivos de outros produtores, decidiu inc luir em seu manejo Começaram com um projeto piloto em 54 hectares na cultura da soja e, poster ior mente, avançaram pa ra a cana de açúcar
O Gerente destacou que a área tratada com o Microgeo® apresentou uma vegetação mais verde e uma ca na mais sau dável, mesmo durante os períodos de seca Na pr imeira biome tr ia, obser varam um acréscimo de aproximadamente 6 toneladas por hectare em comparação com a área de controle Esse resultado aumentou pa ra 11 TCH na segunda biometr ia e, no momento da colheita real, foi consta tado um ganho de 26 toneladas de ca na por hectare

Nos últimos anos o produtor ating iu a produtividade média de 75 toneladas por hectare “E a cana plan ta aqui na nossa reg ião é difícil, a mé dia fica em 95 toneladas por hectare e com o Microgeo® já contabilizamos

113 toneladas por hectare, um ganho bem significativo”, disse Os resultados em TAH (tonelada de açúcar por hec tare) foram muito expressivos, a área testemunha entregou 11,9 TAH en quanto a área com o uso do Adubo Biológ ico ating iu 15,1 TAH, um in cremento de 3,2 toneladas de açúcar
por hectare “Os resultados da Biotecnolog ia Microgeo® a nível nacional em cana de açúcar na média de 106 áreas com colheita real resultaram num ganho de 9 TCH, 1,3 TAH e um aumento do sistema radicular em 36% Nesse pro dutor os resultados estão acima da
média nacional de entrega da tecno log ia, mesmo em ambientes restr itivos uma excelente perfor mance do cana vial Com esses resultados fica claro a impor tância da recuperação do mi crobioma local, mostrando a relevân cia da par te biológ ica do solo que precisa estar em equilíbr io com os de mais f atores, física e química do solo” detalha Marco Antonio Far ias, Coor denador de Desenvolvimento de Mercado da Microgeo
A l é m d o s b e n e f í c i o s d i re t o s n a p ro d u t iv i d a d e, o u s o d o M i c rog e o ® c o n t r i bu i p a r a a m e l h o r i a d a e s t r u t u r a f í s i c a d o s o l o e a u m e n t o d a quantidade e tamanho das raízes que s ã o e s s e n c i a i s p a r a á re a s c o m s o l o s d e s a f i a d o re s c o m o o s d a re g i ã o d e Piracicaba/SP
“O pessoal ficou tão satisfeito que passamos de querer deixar a reg ião por decidir passar a aplicação do Micro geo® para 100% da área Agora vamos usar ano após ano a biotecnolog ia pa ra repovoar o m icrobioma do so lo nessas áreas, aumentar a diver sidade de microrganismos nesses solos arenosos que estão há muitos anos com ca na em cima de cana, e também já estamos com o projeto de ampliação da Bio fábr ica para aumentar a capacidade de produção do Adubo Biológ ico”, de talhou Alecio
Atualmente a propr iedade conta com uma BIM – Bofábr ica Inteligen te Microgeo® com capacidade de 150 mil litros Até o próximo mês, será inaugurada uma B EM – BioEstação Microgeo® com capacidade de pro duzir 400 mil litros do Adubo Bioló g ico e assim atender 100% da área Tanto a BIM como a BEM, são instaladas pelo time de Infraestrutura da Microgeo® e a aquisição é modelo de comodato. A equipe técnica dá Micro geo® dá total supor te desde a monta gem da biofábr ica, produção do Adu bo Biológ ico, or ientação sobre as for mas de aplicação e acompanhamento das avaliações a campo que comprovam os benefícios da tecnolog ia Sobre a produção on f ar m do bioinsumo, que promove a exclusivi dade da Dig ital Biológ ica, o Gerente entende ser esse um outro diferencial do manejo “No começo a gente não entendia o porquê da matér ia pr ima ser da reg ião, mas com o tempo en tendemos essas peculiar idades e inclu sive fizemos análises que comprovaram que as bactér ias presentes no adubo var iam muito de acordo com a esta ção do ano, por exemplo”, contou Os resultados impressionantes ob tidos com a aplicação dessa tecnolog ia têm per mitido ao produtor per mane cer e prosperar na reg ião, superando os desafios enfrentados pelos solos restr i tivos e pelo clima desf avorável
O sistema convencional de plantio da cana de açúcar parece estar com os dias contados Pelo me nos, essa é a expectativa do Centro de Tecnolog ia Canavieira – CTC, que há mais de dez anos, vem trabalhando no desenvolvimento da cana semente, que promete dar uma nova dinâmica no plantio do canavial
Hoje temos a cana planta, seguida pela cana so ca, com uma perda de aproximadamente 20% de produtividade, depois mais 20%, até que se decida pela renovação do canavial Acabar com esse ciclo e manter a produtividade do broto or ig inal, é a revo lução prometida pela cana semente, que per mitirá que o canavial seja renovado a cada safra
Dados apontam uma estagnação na produtivida de da cana nos últimos dez anos A TCH oscilou en tre 67 e 76,9 toneladas por hectare na última década e, par ticular mente na safra 2021/22, o rendimento ag rícola sofreu for te queda com a sér ie de problemas climáticos – seca, geadas e incêndios nos canaviais –que ating iu o Centro Sul do país
As projeções indicam que o plantio por meio de sementes ar tificiais aumentará em 30% a ofer ta de cana na mesma área Em ter mos comparativos, o plantio convencional, feito com mudas, gerou 69,6 toneladas de cana por hectare em 2021, segundo a Sociedade Nacional de Ag r icultura Já com a semen te, devem ser geradas 90,6 toneladas por hectare Dando fim ao tradicional processo de plantio de ca na com "toletes" (pedaços de cana) Para plantar 1 hectare, é preciso de 15 a 18 toneladas de cana em tolete Já com as sementes, esse mesmo hectare usará apenas meia tonelada.
Para o CEO do CTC, Gustavo Leite, “ o plan tio com sementes desenvolvidas a par tir de embr iões revo l u c i o n a r á o c u l t ivo d a c a n a , p ro p o rc i o n a n d o s i g n i f i c a t ivo s g a n h o s e c o n ô m i c o s , o p e r a c i o n a i s e ambientais Isso se traduzirá em lavouras mais pro dutivas, com maior competitividade para açúcar e


e t a n o l E a t e c n o l og i a t a m b é m s e r á a b a s e p a r a o d e s e n h o d e s e m e n t e s p a r a o u t r a s p l a n t a s q u e s e propagam vegetativamente, como cítr icos, eucalip t o e c e b o l a , e n t re o u t ro s n o B r a s i l e e m o u t r a s par tes do mundo”
De acordo com os pesquisadores, as sementes sintéticas, de cerca de 10 centímetros, são capazes de reduzir em cerca de 2% as f alhas nos canaviais, ao mesmo tempo em que proporcionam ganhos de 7% em sanidade, pela menor incidência de pragas e doenças ou seja, a produtividade pode ser 9% maior que no sistema tradicional, o que já cor responde a um ganho de R$ 7 mil por hectare Outra vantagem é que o produtor não precisará reser var par te de sua área (15%, em média) para os viveiros de mudas, a produção será naturalmente maior
Para Suleiman Hassuani, gerente de pesquisa do CTC, a semente sintética é uma tecnolog ia realmen te inovadora “Ela muda totalmente o conceito do sistema de plantio, ou seja, os sistemas mecanizados que a gente tem hoje, procuram f azer a mesma coi sa que o homem f az, só que com máquinas Já esse sistema não A gente produz o mater ial biológ ico em fábr icas, hoje ainda em laboratór io, e a ideia é levar isso para ser plantada em campo, de uma for ma si milar ao de uma semente, só que é uma cápsula, que leva o mater ial biológ ico Isso simplifica todas as
operações e resultando em mais sanidade e produti vidade para o canavial”, diz
Segundo ele, as novas sementes deverão for mar ca naviais das usinas parceiras para já ter a visão do clien te antes de ter o seu lançamento comercial Atualmen te, canaviais for mados a par tir da nova tecnolog ia já podem ser vistos no CTC, em Piracicaba – SP O d i re t o r c o m e rc i a l d o C T C, L u í s A n t ô n i o Pa e s , t a m b é m d e s t a c o u a i m p o r t â n c i a d o m a i o r banco genético do Brasil de cana de açúcar, man tido pelo CTC na cidade de Camamu, na Bahia “O prog rama de melhoramento genético vem a par tir d e u m c r u z a m e n t o d e va r i e d a d e s Te r u m b a n c o com a diver sidade de características de cana é im por tantíssimo, pois per mite mais flexibilidade e f a c i l i d a d e p a r a f a z e r o s c r u z a m e n t o s e o b t e r a q u i l o que se pretende”, disse Para Paes, a semente sintética é o terceiro pilar de desenvolvimento de tecnolog ia do CTC “O melho ramento genético em pr imeiro lugar ; a biotecnolo g ia para proteção da genética desenvolvida e a pro dução de semente para conseguir ganho de escala e antecipar o uso dessa tecnolog ia”, afir mou Segundo o CTC, a semente de cana, ao lado de novas var iedades, poderá trazer ganhos de produti vidade ao ponto de dobrar a produção de cana no Brasil até 2030
Há mais de dez anos sendo desenvolvida pelo CTC, a semente de cana se aproxima da produção em escala comercial

resíduos para energ ia; utilizar resíduos diretamente nos campos; composta gem tor ta com bagaço da cana de açúcar, entre outros
O cultivo da cana em solos areno sos e orgânicos na reg ião da Flór ida, nos Estados Unidos, abr iu o caminho do CANABIO23 – Em busca da Ca na Regenerativa, no dia 24 de maio, nas dependências do Centro de Cana IAC, em Ribeirão Preto – SP O evento, realizado que prosseguiu no dia 25 também, teve o objetivo de proporcionar o compar tilhamento de conhecimentos e benchmarking téc nico sobre manejo biológ ico, orgâni co e sustentável da cana de açúcar Rosa Muchovej, cientista chefe de solos da empresa nor te amer icana U S Sugar, que emprega o sistema de cana regenerativa, e figura como a maior produtora de cana e açúcar dos Estados Unidos, foi a palestrante que abr iu o evento Ela f alou das etapas do trabalho de coleta e processamento do solo, realizado pela U S Sugar, que em
seguida são conduzidas ao laboratór io, onde é feita análise nutr icional Rosa destacou também o trabalho de aná lise foliar

“Os resultados são usados para ve r ificar o status nutr icional da cultura e cor reções são efetuadas caso a colhei ta seja tardia As cor reções são feitas para o próximo plantio ou para cana soca ” , explicou Muchovej A cientista f alou também sobre o conceito da ca na regenerativa, que basicamente de fende que é possível produzir, recupe rando a ter ra e preser vando o meio ambiente, restaurando solos deg rada

dos, conser vando espécies poliniza doras, aumentando a captura de car bono e a retenção de água no solo Muchovej discor reu sobre algumas das técnicas do sistema de cana rege nerativa aplicadas pela U S Sugar : ro tação de culturas é uma for ma de quebrar ciclos, lembrando a que a planta de cober tura mais usada é a crotalár ia; diminuir a aragem no solo; diminuir maquinár io nos campos; otimizar uso de combustíveis/emissão de gases; diminuir o uso de herbicidas (tecnolog ia); conser var os solos (solos orgânicos – alagamento); utilizar os
Uma característica típica da reg ião da Flór ida é o controle de roedores, que provocam perdas que var iam de 15 a 20 milhões d e dólares anuais Rosa conta que o controle biológ ico é feito com cor ujas, predadores natu rais desses roedores “Em 2022 havia 30 caixas instaladas para abr igar as aves Em 2023 foram implantadas mais 100 caixas e existem 400 em constr ução A meta é de 1000 novas caixas nos pró ximos dois anos ” , disse Muchovej Em relação aos meios tecnológ i cos ela destacou o trabalho na área de ag r icultura de precisão, automação, ar mazenamento e análise de dados, sensor iamento remoto, consultor vir tual, Inteligência Ar tificial e conecti vidade Segundo Muchovej a adoção da cana regenerativa vem trazendo re sultados expressivos na produtividade “Em nossos campos a produção con tínua aumentando No solo arenoso, onde o manejo é mais difícil, nas três colheitas que f azemos, produzimos uma média de 98 toneladas por hec tare e no solo orgânico de 150 a 160 toneladas”, infor mou
Resultados expressivos no canavial e um dos destaques do CANABIO23, o Plantio Ver tical, manejo que vem apresentando ótimos resultados na Usina Estivas (RN), desper tou o in teresse dos par ticipantes do evento
O diretor ag rícola Hélio Bar ros e sua equipe, responsáveis pela implan tação, avaliam que além de ótimos re sultados o sistema de plantio ver tical promete revolucionar a cultura da ca na Segundo Bar ros, o planejamento da usina é de que até o próximo verão, 100% do plantio em escala comercial, seja feito através deste sistema
“O que estamos f azendo é nada mais do que aprofundar a muda no fundo do solo, a 80 cm de profundi dade Junto a isso existe uma cesta de tecnolog ias, que envolvem a par te de nutr ição, fitopatolog ia, aplicação de polímeros com a função de ar maze namento de água do solo, que estão f azendo com que nossa muda cresça numa condição diferenciada de todos
os plantios convencionais existentes aqui na reg ião”, infor ma Em sua apresentação no CANA BIO23, Bar ros abordou detalhes do plantio ver tical e suas etapas: subsola gem; adubação; aplicação de ge l e aplicação de defensivos Apresentou imagens e números comparativos en tre diver sas var iedades de cana e seu desempenho, em relação às técnicas de
plantio convencionais, lembrando que 100% da colheita na usina Estivas é feito de for ma mecanizada Bar ros detalhou o compor tamen to e desenvolvimento do sistema ra dicular com o plantio ver tical em am bientes de ir r igação de salvação e de gotejo subter râneo, com a utilização de algumas var iedades, proporcionan do ganhos de produtividade que va r iam de 18% a 44%, a de pender da var iedade utilizada
Diante dos resultados expressivos a técnica de plantio ver tical já vem sen do utilizada em escala comercial “Co meçamos plantando no ano passado 50 hectares em na escala comercial Nes te último verão já avançamos para 500 hectares em escala comercial Agora no inver no tivemos um plantio de 1 500 hectares, sendo 50%, ou seja, 750 hec tares, já no plantio ver tical E no pró ximo verão iremos para integ ralidade na usina, com a adoção de 100% do plantio ver tical”, infor mou Bar ros
Foram dois dias compar tilhamento de conhecimentos técnico sobre manejo biológico, orgânico e sustentável da cana
A técnica que vem apresentando resultados surpreendentes foi um dos destaques do CANABIO23
cionando maior fotossíntese líquida.
“O manejo biológ ico do sistema ag rícola é a nova fronteira para a alta produtividade da cana de açúcar” A afir mação é do professor titular da UNESP de Botucatu, Carlos Cr usciol, durante sua palestra no CANABIO23 Com o tema “Condicio nador biológ ico de solo melhora a eficiência fisio lóg ica e de uso da água e incrementa a produtivida de da cana de açúcar”, o professor Cr usciol avalia que os bioinsumos compostos por um pool de mi crorganismos benéficos podem melhorar o equilí br io biológ ico do solo
De acordo com o professor, o “ emprego desta tecnolog ia pode melhorar a eficiência do uso de fer tilizantes, promover a conser vação do solo e au mentar a produtividade da cana de açúcar de for ma sustentável” O professor destaca a alta biodiver sidade de microrganismos exclusivos e adaptados ao local de uso “São uma média de 300 g r upos dife rentes de microrganismos, de 107 a 109 células de microrganismos/mL

No exper imento apresentado por Cr usciol du
rante a palestra, o condicionador biológ ico de solo alterou parâmetros fisiológ icos da cana de açúcar, contr ibuindo para a maior assimilação e menor concentração de CO2 na câmara subestomática, au mentando, assim, a eficiência de carboxilação Além disso, aumentou a eficiência do uso da água, propor
O estudo foi feito a par tir do uso do adubo bio lóg ico produzido com MICROGEO®, que utiliza a tecnolog ia exclusiva de Compostagem Líquida Contínua (CLC) para nutr ir, regular e manter a pro dução contínua do adubo biológ ico A solução da Microgeo é única no mercado, pois não apenas for nece nutr ientes, mas também maneja e restabelece o microbioma do solo, possibilitando sua aplicação em qualquer cultura e condições climáticas “O condi cionador biológ ico de solo contr ibuiu para o au mento da atividade enzimática da fosf atase ácida do solo no pr imeiro ano e das 3 enzimas indicadoras da qualidade microbiológ ica do solo no segundo ano (fosf atase ácida, beta glucosidase e ar il sulf atase)”, explicou o professor

Os resultados indicaram ainda que no pr imeiro ano, o condicionador biológ ico de solo incremen tou a TCH na ordem de 10% (11 t colmos ha 1), e 8% para a TAH (1,2 t açúcar ha 1)
No segundo ano, o incremento de produtividade foi ainda mais pronunciado, na ordem de 18% para TCH (17 t colmos ha 1), e 19% para a TAH (2,5 t açúcar ha 1) Com base nesse estudo, o professor Cr usciol conclui que o uso continuado do condicio nador biológ ico de solo proporciona: melhor ia da qualidade química e microbiológ ica do solo, maior número de colmos industr ializáveis por metro e maior produtividade de colmos e açúcar
Condicionador biológico melhora a eficiência fisiológica do solo e incrementa a produtividade
Ainda há muito que explorar no microuniver so da microbiolog ia do solo Segundo o professor da Esalq, Fer nando Dini Andreote, ainda sabe mos muito pouco sobre este univer so “Tudo que a gente for f alar de biológ ico nesse sistema de ag r icultu ra não passa de 10 anos Isso leva a uma conclusão impor tante: a gente não sabe tudo da par te de microbiológ i cos, a gente não sabe nem da metade, talvez só 30% Então estamos todos li dando com uma coisa nova, que às vezes parece difícil, mas nem sempre é difícil”, disse em sua palestra no CA
NABIO23
Segundo ele, a essência da mág ica consiste em colocar a genética da planta no melhor ambiente possível Esse ambiente se divide em atmosfera e solo Para um bom desenvolvimen to o solo saudável tem que contar com qualidade química, biológ ica e física, a fim de promover o confor to necessá r io para o máximo desenvolvimento das plantas cultivadas!
Andreote também destacou que o mercado de produtos biológ icos na ag r icultura vem num crescente De 3% para 36% das área s cultivadas entre 2016 e 2022 “Trata se de uma g ran de evolução em número de produtos e classes de funções Lembrando que a cana de açúcar é uma das culturas que mais usam insumos biológ icos”, infor mou o professor
No evento, Raff aella Rossetto, pesquisadora científica IAC, f alou so bre Microrganismos e Solubilização de fosf atos Ela explicou que diferente mente do nitrogênio e do carbono, o ciclo do fósforo não tem compar ti mento atmosfér ico Os solos brasileiros, tem pouco P (80% dos solos) – 2 a 5 mg dm 3, no entanto, existem uma poupança que pode ser aproveitada


A pesquisadora infor mou que pa ra se ter boas respostas com a inocu lação de microrganismos solubiliza dores de P, é preciso que se tenha P no solo, que o inóculo esteja reg istrado no MAPA, ver ificando se prazo de vali dade e seguindo as instr uções, que ele seja ar mazenado em local fresco, e que seja feita a adubação com aplicação do inóculo no mesmo dia, de preferência
no final da tarde (20 a 25º), condições boas de umidade do solo e do ar, além do pH cor r ig ido
De acordo com a pesquisadora, os solubilizadores de fosf atos estão mos trando potencial para uso em cana Ela lembra que os microrganismos são tão mais eficientes quanto melhor forem as condições para seu crescimento e que os solos com boa fer tilidade têm maior chance de obter respostas da inoculação com solubilizadores de fosf atos
O pesquisador do Instituto Bio lóg ico, José Eduardo Marcondes, des
tacou ações para o controle biológ i co de bicudo da cana, Sphenophor us levis, que incluem a destr uição mecâ nica da soqueira na época apropr iada;
a manutenção da área destr uída livre de vegetação hospedeira por um pe ríodo prolongado, acima de 3 meses; a aplicação no sulco de plantio do inse ticida fipronil 800 WG (250 g/ha) ou thiametoxam 250 WG (0,8 a 1,5 kg/ha) e uso de iscas tóxicas, que tem mostrado cer ta eficiência no controle de adultos
William Trevisan, gerente de Pro dutos e Mercado da HinoveBioFer tilizantes Especiais apr imorados biolog icamente com tecnolog ia Bio wish, destaca que de acordo com White et al (2018), os endófitos r izo fág icos trazem uma capacidade de aquisição de nutr ientes baseada nas raízes para seus hospedeiros que a planta sozinha não possui “Em outras palavras, a parcer ia planta microorga nismo está mais bem equipada para absor ver nutr ientes do solo do que a planta estar ia sozinha”, disse Gabr iela Vieira, gerente do Centro Biotecnológ ico da Biomassa, na Uisa, f alou sobre práticas regenerativas para altas produtividades, um trabalho que segundo ela vai além da agr icultura sus tentável e preconiza a saúde do solo João Ulisses de Andrade, diretor da AGR cana f alou sobre manejo cons ciente com produtos biológ icos e destacou momentos impor tantes no planejamento nos aspectos fisiológ ico: colmo atinge o máximo de ar maze namento de sacarose; Botânico: quan do as gemas estão em condições de dar or igem a novas plantas; e econômica: quando atinge teor viável para o pro cesso industr ial
Fred Polizello, diretor ag rícola da Usina São Domingos destacou que através do desenvolvimento, Integ ra ção e aplicação de inovações e tecno log ias no campo, assunto que foi tema de palestra, a usina pretende passar das atuais 2 725 000 toneladas de moagem para 3 500 000 toneladas na safr a 2026/27 O que inclui a utilização de Autopilot
GPS; preparo solo cantei r izado; uso Tráfego Controlado; tele metr ia equipamentos (Ganho Perfor mance) e monitoramento Câmeras
A busca da cana regenerativa deu o tom das palestras realizadas nos dois dias do CANABIO23 Opor tunidades e resultados na estratég ia de manejo fisiológ ico e nutr icional foi o tema da palestra do engenheiro ag rônomo, Diego da Mota Fer reira, diretor da MDGAg ro, que destacou que a nutr i ção de plantas está intimamente rela cionada com a fisiolog ia, manejo bio lóg ico, bioestimulantes e o complexo de macro e micronutr ientes


Manejo Biológ ico e Fisiológ ico para cultura da cana de açúcar, tam bém foi tema da apresentação de Cel so Luiz da Silva, da SUMITOMO, que apresentou soluções sustentáveis com o objetivo de melhor ia e proteção de cultivos através de saúde do solo e r i zosfera, controle biológ ico de pragas e reguladores de crescimento
Na sequência, Michel da Silva Fer nandes, diretor da MS Fer nandes Consultor ia, f alou sobre o manejo in teg rado para alta produtividade da ca na de açúcar Segundo ele, químicos e biológ icos atuam efetivamente con tra o avanço de nematóides, no entan to, um cuidado deve ser avaliado área a área, pela pressão, histór ico de pro dutos entre outros.
Serg io Luiz de Almeida, gerente Técnico da PHC – Amér ica do Sul, f alou sobre insumos inovadores como base para uma ag r icultura regenerati va, com destaque para a H2COPLA, uma proteína que se liga ao receptor
de proteína na parede celular do teci do vegetal Estratég ias sustentáveis para o controle de pragas, foi o tema condu zido por Thiago de Paula, gerente de Fitotecnia da BP Bunge Bioenerg ia, para quem é preciso dar condições e deixar os microrganismos trabalharem
Aloísio Meloni, gerente técnico cor porativo da Viter ra Bioenerg ia, f a lou sobre o trabalho realizado pela usina no uso de produtos biológ icos no controle integ rado de pragas e doenças e na f er tilidade da cana de açúcar
Já Serg io Victor, da Mor ro Verde explanou sobre fer tilizantes sustentá veis em busca d a fer tilidade carbono zero, destacando a missão da empresa em se tor nar a referência brasileira na
produção de fer tilizantes naturais pa ra a ag r icultura bio regenerativa e de baixo carbono
Controle Biológ ico de Fungos Fi topatogênicos na cana de açúcar da Usina Cer radão, foi o tema da bióloga Sabr ina Dibelli A usina iniciou o tra balho de manejo biológ ico no ano de 2009, com uso da cotesia, e em 2020 já contava com 100% de biológ ico (ne maticida no sulco e inseticida)
O aumento da complexidade mi crobiológ ica no solo e somatór ia de efeitos na cana de açúcar foi o tema da palestra do professor Dr Kenji Au gusto Senô, da Faculdade Dr Francis co Maeda e diretor técnico e de ino vação da Ecobhio Tecnolog ia "Esta mos tratando de complexidade mi crobiológ ica no solo, na r izosfera e fi losfera E estamos trabalhando com a somatór ia de efeitos na cadeia produ tiva da cana de açúcar", destacou o professor
P ro d u ç ã o, t r a n s p o r t e, ava l i a ç ã o, a p l i c a ç ã o e a c o m p a n h a m e n t o s ã o a s a ç õ e s q u e c o m p õ e m a m e t o d o l og i a
P T 3 A s , i m p l a n t a d a p e l a Te c n o d ro n e s A g ro, b r a ç o d a a g r i c u l t u r a d e p re c i s ã o d o G r u p o B i o f l o r a , c o m a u t i l i z a ç ã o d e d ro n e s , n o t r a b a l h o d e
c o n t ro l e d e p r a g a s d a c a n a d e
a ç ú c a r Fe r n a n d o T i n o, p re s i d e n t e d o
G r u p o B i o f l o r a , a f i r m o u q u e a u t i
l i z a ç ã o d o s d ro n e s é p a r t e d e u m
p ro c e s s o q u e t e m c o m o b a s e o c o n
t ro l e d e p r a g a s d a c a n a
Em cinco anos, BP Bunge avança
no uso de biológ icos O passo inicial se deu em 2019, através do controle de pragas e hoje se espalha em outros segmentos da produção Segundo Ger mano Caetano de Souza, consul tor técnico cor porativo de Tratos Culturais da companhia, eles evoluí ram numa crescente exponencial, chegando a quase 1 000% em apenas cinco anos
No Gr upo Olho D’água o mane jo com a utilização de biológ icos é antecedido por cr iter iosa avaliação Marcos Fer reira de Mendonça, asses sor de Diretor ia do Gr upo, destacou que um dos pr incipais pontos que de vem ser levados em consideração é a racionalização do uso de insumos “Não adianta nada, usar o biológ ico de qualquer for ma ” , adver tiu
A Canaoeste destacou a implan tação de uma biofábr ica voltada para o atendimento dos associados Segundo o gestor, André Bosch Volpe, “inicial mente vamos começar a trabalhar com dois produtos para evitar r iscos, mas já temos planejada a próxima etapa, bus cando parcer ias com o objetivo de desenvolver soluções mais específicas para tor nar nosso manejo mais efi ciente”, explicou
Já Dane Avanzi, advogado espe cialista em Direito Aeronáutico e CEO do Gr upo Avanzi, discor reu so bre a operação com drones, f alando sobre os proc edimentos e reg ras es senciais atualizados, apr imorando as políticas ESG
Ao longo dos dois dos eventos os palestrantes apresentaram diversas soluções através da utilização de biológicos













































O Road Show da Transformação Digital passou mais uma vez pela Usina Uberaba Os representantes Josias Messias, diretor da Pró Usinas e ProCana e Ângelo Barboza foram muito bem recebidos pelo gerente industrial,Vicente Machado e o supervisor de produção industrial, Afonso Marinho Foi uma excelente opor tunidade de conferir de perto a produtividade e eficiência da usina



A edição 2023 do CanaTech realizado em Uberada no dia 1º de junho contou com uma excelente organização e com conteúdo relevante para o setor com par ticipações de qualidade tanto na programação, quanto no público Figuras importantes do cenário sucroenergético, como Pedro Isamu Mizutani, conselheiro da Co san, Antônio Garcia Cordeiro e Sérgio Varela, da Usina Agropeu e Alécio Cantalogo Junior, da Usina Bevap marcaram presença no evento

A Usina São Domingos, em Catanduva SP, aposta no bom desempenho da safra 2023/24 e in veste na moder nização de sua planta industr ial, com a aquisição de quatro ter nos de moenda, ampliando sua capacidade de moagem para 3 milhões de tone ladas de cana de açúcar

“O investimento da usina provoca um impacto positivo na economia da reg ião, pois espera se que m a i s e m p re g o s s e j a m g e r a d o s e q u e h a j a u m a u mento no volume de vendas, o que pode impulsio nar o desenvolvimento econômico do município de Catanduva e das cidades vizinhas”, afir mou Sérg io M a c h a d o, g e re n t e d e R e c u r s o s H u m a n o s d a S ã o Domingos
Machado ressalta que, com a aquisição dos no vos ter nos de moenda, a Usina São Domingos for talece ainda mais a sua posição de destaque no setor e reforça o seu compromisso com a excelência em seus processos produtivos
Ao todo, foram comprados 4 ter nos de moenda
Dedini 42” x 78”, que per tenciam à Usina Floralco, que se encontrava desativada Para a aquisição dos equipamentos, a São Domingos contou com o su por te da E Machine S A, empresa brasileira sedia da em Ser tãozinho SP, especializada na compra e venda de equipamentos industr iais e maquinár ios ag rícolas
Segundo Milton Fer reira Gomes Filho, CEO da E Machine S A, mesmo durante a pandemia, hou ve um crescimento exponencial na ofer ta e na co mercialização de usados, tanto no Brasil quanto no exter ior A Cia , que atua na Amér ica Latina, Áfr ica e Ásia, estima, para 2023, um crescimento para o segmento em tor no de 20% Fatores como preço competitivo, prazo de en trega enxuto, tecnolog ia embarcada e possibilidade de retrofit contr ibuem para esse cenár io A empresa estima que a diferença de preço pode var iar de 40% a 60% em relação a um equipamento novo, o que
estimula o investimento na melhor ia das plantas in dustr iais, através da aquisição de equipamentos Uma impor tante garantia para a e mpresa que compra estes equipamentos é o sistema de laudos desenvolvido pela E Machine, assegurando as con dições de funcionamento do maquinár io Feito por uma empresa terceir izada, ou pelo própr io f abr ican te, o equipamento passa por uma minuciosa visto r ia, que indica tudo o que precisa ser feito para que ele possa entrar em operação “O trabalho é tão completo que, na época da pandemia, chegamos a fechar negócios enviando apenas o laudo, sem que o comprador precisasse ver a máquina”, infor mou Gomes Filho

Além de máquinas e equipamentos, a compa n h i a t a m b é m ve m s e n o t a b i l iz a n d o p e l a ve n d a d e u n i d a d e s i n t e i r a s A e xe m p l o d a ve n d a d e u m a planta industr ial completa para a Ser pasa Ag roin dustr ial, do Gr upo Paranhos, que iniciou suas ati vidades em 2022, na cidade baiana de Muquém do São Francisco
Foi a pr imeira usina sucroenergética do Polo Ag roindustr ial e Bioenergético do Médio São Fran cisco a funcionar no local, além de ter contr ibuído também para a expansão da Usina Santa Mar ia, tam bém no estado baiano “É uma for ma de cooperar mos para a expansão e o desenvolvimento do setor bioenergético, proporcionando novas possibilidades de implantação de negócios”, finaliza Gomes Filho
Com a aquisição de 4 ternos de moenda, a capacidade de processamento da usina ultrapassa 3 milhões de toneladas de cana por safra

Companhia transformou o cenário econômico do extremo sul da Bahia, implantando a cultura da cana-de-açúcar
Usina Santa Mar ia e investimento são praticamente sinônimos na cidade de Medeiros Neto, situada no extre mo sul da Bahia Foi nesta cidade, há quase cinco décadas, que a usina se instalou e implantou a cultura da ca na de açúcar que inexistia na loca lidade A Santa Mar ia, transfor mou a economia da reg ião, até então, dire cionada pr imordialmente para a cr ia ção extensiva de gado
Graças ao olhar empreendedor dos seus dir igentes, a companhia vem apresentando consistente crescimento em volume de cana processada, se guindo a expectativa de manter a pro g ressividade evolutiva na produção de etanol Dando continuidade ao seu projeto de expansão, a companhia pioneira da cana na Bahia quer adoçar
a receita, investindo na aquisição de maquinár io e equipamentos para a produção de açúcar
Para a safra 2023/24, iniciada em 1°de abr il, a expectativa é de uma moagem de 2,3 milhões de toneladas de cana e uma produção de 1 800 000 m3/etanol Os investimentos em aquisição de equipamentos seguem o fluxo planejado por sua diretor ia, que contempla mais uma matr iz de ener g ia limpa e renovável com a sua co geração de energ ia a par tir da biomas sa da cana de açúcar (bagaço)
A u s i n a e s t á i nve s t i n d o R $ 1 5 0 m i l h õ e s n a i m p l a n t a ç ã o d e u m a t e r m e l é t r i c a e n a p ro d u ç ã o d e a ç ú c a r S e g u n d o a d i re ç ã o d a e m p re s a , “ o s i nve s t i m e n t o s s ã o c o m re c u r s o s p r ó p r i o s D e s t a f o r m a s e g u i m o s c re s c e n d o, i nve s t i n d o re c u r s o s e g e r a n d o e m p r e g o s , r e n d a , t r i b u t o s , b e m e s t a r s o c i a l e a m b i e n t a l a o s mu n i c í p i o s d a re g i ã o d o e x t re m o s u l d a B a h i a "
A implantação da ter moelétr ica, com capacidade de 65 MW, já se en contra em f ase de execução Já a usina para produção de açúcar do g r upo, terá uma produção estimada em 14 000 sacos /dia O projeto já está em andamento e a planta está sendo er guida na unidade de Medeiros Neto Sempre atento às g randes opor tuni
dades, a Santa Mar ia adquir iu par te dos equipamentos da extinta usina Floralco, localizada na reg ião noroes te do inter ior paulista
A compra de maquinár io de uma usina desativada, foi uma solução ado tada visando a redução de custos e também para ag ilizar o início da pro dução “Este investimento é para que nós possamos preparar a nossa planta para produzir açúcar, a par tir de 2024 Os equipamentos já estão chegando A planta baixa já está pronta Estamos esperando chegar outros complemen tos de equipamentos para dar mos prosseguimento à implantação”, in for mou Marcos Antônio Costa Lemos, gerente de Relações Institucionais da Santa Mar ia
Costa também destaca a ação de sustentabilidade envolvida neste tipo de aquisição “A gente acaba trazendo a atividade, negócios que deixaram de existir, cumpr indo com a nossa missão de sustentabilidade É impor tante olhar para essas plantas e dar funcio nalidade para elas, com um novo olhar de desenvolvimento industr ial, focado em resultados, mas sobretudo em ob ter esses equipamentos, que se encon travam em desuso, para que a gente dê a utilidade adequada Com isso, nós cumpr imos a nossa percepção am biental " , ressaltou Costa
A a q u i s i ç ã o d o s m a q u i n á r i o s c o n t o u c o m o s u p o r t e d a E M a c h i n e S A , e m p r e s a b r a s i l e i r a e s p e c i a l i z a d a n a c o m p r a e ve n d a d e e q u i p a m e n t o s i n d u s t r i a i s e m a q u i n á r i o s a g r í c o l a s , q u e e s t á r e s p o n s á ve l p e l a g e s t ã o d a ve n d a d o s a t i v o s d a F l o r a l c o “ P a r a o c o m p r a d o r , a a q u i s i ç ã o d e s s e s a t i v o s n ã o d e s t o a d a s p r á t i c a s m o d e r n a s d e g e s t ã o, q u e p r e c o n i z a m o i n v e s t i m e n t o e m t e c n o l o g i a d e p o n t a , p o i s , a p e s a r d e e s t a r e m e m u s o, c o n t a m c o m a m e s m a t e c n o l o g i a e m b a r c a d a , u t i l i z a d a e m n o vo s e q u i p a m e n t o s , c o n t a n d o a i n d a c o m a v a n t a g e m d e p r o p o r c i o n a r u m r e t o r n o m a i s r á p i d o a o c a p i t a l i n v e s t i d o ” , a r g u m e n t a M i l t o n F e r r e i r a G o m e s F i l h o, C E O d a E M a c h i n e S A S o b re a n ova e t a p a , o p re s i d e n t e d o G r u p o S ã o L u i z , L u i z C a r l o s Q u e i rog a , a f i r m a : “ E s p e r a m o s d e s t a f o r m a c o n c l u i r m a i s u m i m p o r t a n t e c i c l o d e d e s e nvo l v i m e n t o d e n o s s a s u n i d a d e s , l e m b r a n d o s e m p re d a g e r a ç ã o d e e m p re g o s , re n d a , t r i bu t o s , b e m e s t a r s o c i a l e a m b i e n t a l a o s mu n i c í p i o s d a re g i ã o d o e x t re m o s u l d a B a h i a Ta i s ava n ç o s s ã o re f l e x o s d o s i nve s t i m e n t o s n a m o d e r n i z a ç ã o d a s á re a s i n d u s t r i a l e a g r í c o l a d a U s i n a S a n t a M a r i a ” , d e s t a c a

A Unidade Santa Vitór ia, localiza da em Santa Vitór ia – MG, começará a produzir açúcar na safra 2024/25, in for mou a Jalles nesta sexta feira (22)
A companhia investirá R$ 170 milhões em uma nova fábr ica, que te rá capacidade de produzir 15 000 sa cas de 50kg de açúcar VHP (equiva lente a 750 toneladas) por dia, totali zando 150 mil toneladas por safra

Com esse investimento, a Unida de Santa Vitór ia, que hoje possui 100% do seu mix voltado para a produção de etanol, poderá ter maior flexibilidade (etanol x açúcar), podendo chegar em até 52% do seu mix para açúcar
A nova fábr ica possibilitará o mix total de produção da companhia, in
cluindo as suas 3 unidades, a ser de até 51% para açúcar, consi derando em ambos os casos, o cenár io máximo na produção de açúcar para a safra de 2024/25
De acordo com a Jalles, o projeto para a implantação da nova fábr ica foi aprovado refletindo a conjuntura atual de mercado e em cumpr imento ao disposto na Res olução CVM n º
44/21 e às melhores práticas de go ver nança cor porativa
“A companhia irá seguir em con sonância à sua política de ge rencia mento de r isco de preço de commo dities, trabalhando para proteger o seu fluxo de caixa Os impactos positivos esperados são: a maior flexibilidade do mix para a produção de açúcar, que passará a incluir o açúcar VHP desti
nado à expor tação; o aproveitamento do bom momento do preço da com modity; a mitigação dos r iscos do ne gócio devido à maior diver sificação do mix de produtos e aumento da repre sentatividade da receita no mercado exter no ” , infor ma a Jalles, em comu nicado assinado por Rodr igo Penna de Siqueira, diretor Financeiro e de Relações com Investidores
A Atvos anuncia uma mudança em sua estr utura de capital com a transfe rência de R 6,4 bilhões de títulos de dívida para a Soneva Energ ias Reno váveis S A, um veículo financeiro do FIP Ag roenerg ia, atual controlador Com isso, Soneva passa a deter 90% do controle acionár io da companhia, que é atualmente uma das maiores produ toras de biocombustíveis do Brasil

A par tir dessa medida, a dívida br uta da empresa foi reduzida em 50%, e terá alongamento do prazo de ven cimento das obr igações vigentes até 2043, com taxa de juros reduzida e possibilidade de início dos pr im eiros pagamentos em três anos
Além disso, a Atvos dá mais um passo impor tante em direção à chega da da Mubadala Capital, uma empresa global de gestão de ativos, que já havia
anunciado a intenção de realizar in vestimentos de R 500 milhões na companhia A par tir da reestr uturação da dívida e aliado a esse apor te inicial, a Atvos prevê investir R 1,6 bilhão nas áreas ag rícola e industr ial ainda nessa safra Esse movimento está em linha com o planejamento de longo prazo do novo acionista, que visa expandir a capacidade de produção da companhia para alcançar a moagem de 30 milhões de toneladas de cana de açúcar nas próximas safras
“ A l c a n ç a m o s u m p e r f i l d e d í v i d a a d e q u a d o à re a l i d a d e a t u a l d e n o s s a s o p e r a ç õ e s , p ro p o rc i o n a n d o a s o l i d e z n e c e s s á r i a p a r a q u e p o s s a m o s re a l i z a r a p o r t e s e m n o s s a s u n i d a d e s a g ro i n d u s t r i a i s , n ovo s n e g ó c i o s , i n ova ç ã o, n o d e s e nvo l v i m e n t o d e n o s s a s p e s s o a s , c o mu n i d a d e s e d e t o d a a c a d e i a p ro d u t iva ” , a f i r m a B r u n o S e r a p i ã o, q u e d e s d e m a i o d e 2 0 2 3 o c u p a a p o s i ç ã o d e C E O d a A t vo s “ É u m m ov i m e n t o f u n d a m e n t a l p a r a q u e p o s s a m o s e n c e r r a r e m b reve o p ro
F inanciamento paga a operação DIP F inance do encerramento da recuperação judicial
O Gr upo Moreno fez a emissão de uma CPR Verde com um g rande banco no valor de R$ 450 milhões no início deste mês Com esse apor te, a companhia liquidou o saldo das ope rações DIP Finance contratadas no encer ramento do processo de recupe ração judicial, que ocor reu, antecipa damente, há cerca de 1 ano e meio
“ A o p e r a ç ã o f o i t o t a l m e n t e n e g o c i a d a p a r a q u e a c o m p a n h i a t ro c a s s e u m re c u r s o c a ro, p o r c u s t o s a valor de mercado Esta é a prova de finitiva que viramos a pág ina e vive m o s u m g r a n d e m o m e n t o, c o m p e r s p e c t iva s e x c e l e n t e s j á p a r a u m f u t u ro p r ó x i m o ” , c o m e m o r a Fe l i p e Moisés, diretor comercial e financei ro da Moreno A estratég ia acer tada é mais um capítulo de sucesso no reer
guimento do Gr upo Moreno, inicia do em 2019
Em janeiro do ano passado, a em presa anunciou o encer ramento da recuperação judicial com o pagamen to de R$ 1 bilhão aos credores O acer to, realizado em par te com recur sos própr ios, gerados na safra 2021/22, e o restante, cerca de R$ 600 milhões, com dois empréstimos DIP Finance A operação de financiamento, pouco
usual, per mitiu ao Gr upo Moreno manter todo o seu ativo, incluindo as três usinas localizadas no inter ior de São Paulo, em Luiz Antônio, Monte Aprazível e Planalto
“Geralmente as empresas do setor em dificuldades financeiras acabam vendendo ativos ou f alindo”, explica Moisés Agora, com o negócio já rea lizado com uma instituição bancár ia, o g r upo garantiu taxas de juros e prazo
ce s s o d e re c u p er a ç ã o ju di c i al d e f o r m a f o r t a l e c i d a e c o m u m a s a ú d e f i n a n c e i r a ro bu s t a p a r a s e g u i m o s f i r m e s e m n o s s o p ro p ó s i t o ” , f i n a l i z a N a ú l t i m a s a f r a , a A t vo s p ro c e s s o u 2 2 , 4 m i l h õ e s d e t o n e l a d a s d e c a n a , o q u e p e r m i t i u a p ro d u ç ã o d e 1 , 6 b i l h ã o d e l i t ro s d e e t a n o l , 3 8 2 m i l t o n e l a d a s d e a ç ú c a r V H P e a c o g e r a ç ã o d e 2 , 1 3 2 m i l G W h d e e n e r g i a e l é t r i c a a p a r t i r d a b i o m a s s a , a l é m d a e m i s s ã o d e 2 , 2 m i l h õ e s d e C r é d i t o s d e D e s c a r b o n i z a ç ã o ( C B I O s ) A e m p re s a p o s s u i o p e r a ç õ e s e m q u a t ro e s t a d o s ( G o i á s , M a t o G ro s s o, M a t o G ro s s o d o S u l e S ã o Pa u l o ) e c o n t a c o m m a i s d e 9 m i l i n t e g r a n t e s d i s t r i b u í d o s e m n ove u n i d a d e s a g ro i n d u s t r i a i s e d o i s e s c r i t ó r i o s c o r p o r a t ivo s Recentemente, a companhia re n ovo u o s e u p ro p ó s i t o d e n e g ó c i o : “ P ro d u z i m o s e n e r g i a l i m p a q u e m ove o mu n d o e t r a n s f o r m a v i d a s ” , p a u t a d o e m n ova s c re n ç a s f u n d a m e n t a d a s e m C u i d a d o, I n t e g r a ç ã o e Tr a n s f o r m a ç ã o, q u e i n s p i r a m a s a t i t u d e s n o m o d o d e a t u a r c o m t o d a a s u a c a d e i a p ro d u t iva
para pagamento que per mitem am pliar ainda mais suas condições de in vestimento
“Lá atrás tivemos que trabalhar com recur sos caros, mas conscientes de que era a posição necessár ia, transitó r ia e mais indicada naquele momento Hoje concluímos que o plano foi acer tado, pois conseguimos mostrar para o mercado nossa plena recupera ção e reestr uturação, obtendo novas e melhores condições para prosseguir a jor nada de crescimento da compa nhia”, completa o diretor
Fundado em 1981, o Gr upo Mo reno gera atualmente cerca de 8 mil empregos, diretos e indiretos A ex pectativa na safra 2023/24 é moer mais de 10,5 milhões de toneladas de cana de açúcar, um incremento de 35% em relação ao período anter ior, produzindo 14 milhões de sacas de açúcar e 380 milhões de litros de eta nol, consolidando como uns dos 10 maiores player s do setor sucroenergé tico com capacidade instalada de moagem de 13 milhões de toneladas

Companhia prevê investir R$ 1,6 bi na indústria e no campo na safra 2023/24
Em plena pandemia, a massa f ali da da antiga usina Pau D’Alho come çou a ser moder nizada por três de seus for necedores de cana de açúcar, que em iniciativa inusitada, assumiram a empresa paralisada há sete anos
Hoje, com a safra 2023/24 em pleno andamento, a rebatizada Ener sugar Bioenerg ia deve processar 1,4 milhão de toneladas de cana, aumento de 40% sobre o total da safra anter ior


É a terceira safra seguida com crescimento expressivo, consolidando uma histór ia de sucesso a par tir da aposta de três for necedores que, a par tir de 2017, decidiram virar usineiros
O tr io investiu mais de R$ 100 mi lhões de capital própr io e de investi dores, sem recor rer a bancos A inicia tiva gerou mais de 1000 empregos di retos e indiretos, com for te impacto na
economia da reg ião, no Centro Oes te paulista
“Par timos de 750 mil toneladas na pr imeira safra em 2020/21, para 1 mi lhão de toneladas em 2021/22 e pro jetamos 1,4 milhão para 2022/23, mas esse número contempla apenas o que já está contratado e o total pode ser su perado”, explica o CEO da Enersugar Melchiades Donizete Terciotti, que co manda as operações desde a retomada
O p l a n o d o s n ovo s d o n o s ve m sendo seguido à r isca, com a moder nidade prevalecendo nas relações co merciais e de trabalho Entre os pr in cipais diferenciais, Sylvio Ribeiro do Va l l e e o s i r m ã o s D o r iva l e D i rc e u Finotti decidiram desde o início que a cana comprada de for necedores se r ia remunerada acima do valor defi n i d o p e l o C o n s e c a n a , e n t i d a d e q u e re ú n e f o r n e c e d o re s e re p re s e n t a n t e s
de usinas que, juntos, definem os pre ços com base na medição de açúcares t o t a i s re c u p e r á ve i s ( AT R ) d a c a n a entregue nas usinas
“A refor ma par a o reinício das atividades em 2020 deixou a Ener su gar com capacidade de moer 2,2 mi lhões de toneladas de cana por safra, por tanto a empresa ainda tem espaço para continuar crescendo”, conclui a direção da usina
Empresa reduz os custos da obra, previstos em R$ 2,3 bilhões, para R$ 1,9 bilhão, antecipa inauguração e amplia capacidade produtiva total
A FS expande seus negócios com o início da operação, em 1º de maio, de sua terceira indústr ia, também em Mato Grosso, no município de Pr i mavera do Leste
Foram investidos R 1,9 bilhão na nova fábr ica, que durante as obras ge rou cerca de 8 mil empregos indire t o s , a l é m d e 2 0 5 e m p re g o s d i re t o s para o início das operações A capa cidade total de produção da unidade por ano é de 585 milhões de litros de etanol e 570 mil toneladas de DDGs ( D r i e d D i s t i l l e r s G r a i n s , g r ã o s s e c o s de destilar ia)
A redução de investimento com relação ao provisionado – R 2,3 bi lhões – foi fr uto de otimização de custos e ainda houve ganho com a antecipação do início de operação, que estava previsto para julho
“Inicialmente prevista para o final desse semestre, conseguimos trabalhar de for ma eficiente e antecipar o iní cio das operações”, afir ma o CEO da FS, Raf ael Abud O executivo ainda
complementa: “Pr imavera do Leste é uma reg ião muito impor tante para a FS devido à g rande ofer ta de milho e sua localização estratég ica para distr i buição dos nossos produtos”
A FS possui outras duas unidades industr iais em Mato Grosso, nos mu nicípios de Lucas do Rio Verde e Sor r iso, que juntas somam 1,5 bilhão de capacidade produtiva de litros de eta nol por ano
Com a entrada em operação da unidade de Pr imavera do Leste, a em presa se tor na uma das quatro maiores produtoras de etanol do Brasil, alcan çando capacidade produtiva de mais de 2 bilhões de litros de etanol/ano O pla no de expansão contempla a abertura de mais unidades industr iais no estado de Mato Grosso, com o objetivo de atingir capacidade produtiva de 5 bilhões de li tros de etanol por ano, até 2026
Unidade recebeu investimento de mais de 100 milhões para voltar a funcionar
A indústr ia de açúcar do Brasil tem um enor me potencial de mercado de Bioplásticos Com o crescente interes se global por produtos sustentáveis co mo, por exemplo, o polímero Poliáci do Lático (PLA), novos negócios po dem se abr ir para os produtores de ca na de açúcar no Brasil No entanto, a pergunta que precisa ser respondida é: Como o setor ag rícola pode se fir mar nesse novo mercado?
A equipe da Sulzer Chemtech analisa como a transfor mação de açú cares em bioplástico (PLA) pode be neficiar os ag r icultores e produtores de açúcar brasileiros
Graças aos seus vastos campos de cana de açúcar, o Brasil é o maior produtor mundial de açúcar, exportan do as var iedades br uta e refinado para todo o mundo Por exemplo, em 2020 foram produzidas 45 milhões de tone ladas de cana de açúcar e expor tadas 34 milhões de toneladas de açúcar
Isso significa que há uma excelente oportunidade aos produtores de cana
de açúcar e processadores finais do país que desejam aumentar sua lucratividade
O rápido crescimento na demanda global de bioplásticos pode ajudar as empresas ag rícolas brasileiras a diversi ficar seus mercados, ag regando valor extra aos seus produtos e maximizando as vendas, especialmente quando o pre ço do açúcar está em baixa, impactan do na perfor mance anual do produtor Além disso, essa transição pode ajudar a lidar com o g rande excedente de açú car produzido, que aumenta anualmen te à medida que o consumo global ten de a diminuir S e n d o a s s i m , o m i l h o e a c a n a d e a ç ú c a r p o d e m s e r u s a d o s c o m o matér ias pr imas impor tantes e valio sas para mater iais novos e mais eco l ó g i c o s , c o m o o s b i o p o l í m e ro s d e P L A E l e s p o d e m s e r u s a d o s p a r a p ro d u z i r p l á s t i c o s b i o d e g r a d á ve i s , ajudando a reduzir nossa dependên c i a d e p ro d u t o s b a s e a d o s e m c o m bu s t í ve i s f ó s s e i s n ã o re n ov á ve i s e muitas vezes não recicláveis


Confor me cresce a necessidade de alter nativas sustentáveis ao plástico convencional, o PLA se apresenta co mo uma solução econômica e ver sátil para uma ampla var iedade de diferen tes aplicações Estas incluem matér ias pr imas para impressão 3D, têxteis, dis positivos eletrônicos, componentes au tomotivos e embalagens para os setores de alimentos e bebidas Além disso, embora o bioplástico seja atualmente considerado uma área de nicho, o mer cado está disparando e deve pelo me nos quadr uplicar de tamanho até 2030 Mais e mais empresas nas reg iões da Amér ica do Nor te e Ásia Pacífico, onde a produção de açúcar está no auge, estão se voltando para esse ne gócio, vendendo o PLA e seus inter mediár ios para os mercados domésti cos e inter nacionais
Como essa área de negócio ainda está engatinhando no Brasil, as em presas pioneiras que começarem a
produzir PLA podem se beneficiar da baixa concor rência local Além disso, g raças aos baixos preços do açúcar, eles podem aproveitar as opor tunidades de expor tação global com produtos de custo competitivo à medida que a de manda aumenta
Outro benefício da produção local é que a maior ia das usinas de proces samento de açúcar do Brasil são autos suficientes em energ ia, pois geram ele tr icidade ecológ ica a par tir da cana de açúcar moída e bagaço, reduzindo ainda mais o custo de produção
Ao olhar para a produção susten tável de plástico, essa capacidade pode f avorecer as empresas locais, pois po dem oferecer credenciais mais ecoló g icas, algo altamente desejado Isso é fundamental para apoiar os negócios em toda a cadeia de valor do PLA, minimizando o impacto ambiental do setor como um todo e for necendo produtos ecolog icamente cor retos

Pa r a e n t r a r c o m s u c e s s o n a c a d e i a d e va l o r d o P L A , o s f a b r i c a n t e s p r e c i s a m d e u m p a r c e i ro c o n f i á ve l , c a p a z d e f o r n e c e r s o l u ç õ e s i n t e g r a d a s q u e a t e n d a m a t o d o s o s a s p e c t o s e e t a p a s d a p ro d u ç ã o A S u l z e r, l í d e r e m t e c n o l o g i a d e s e p a r a ç ã o e m i s t u r a , e s t á à f r e n t e d a s s o l u ç õ e s d e e n g e n h a r i a e t e c n o l o g i a s l i c e n c i a d a s p a r a a p ro d u ç ã o, p u r i f i c a ç ã o e p o l i m e r i z a ç ã o d e A L e l a c t í d e o s
A S u l z e r é c a p a z d e p ro j e t a r, e n t r e g a r e i m p l e m e n t a r e q u i p a m e n t o s c o m p l e t o s d e a l t a q u a l i d a d e p a r a a f a b r i c a ç ã o t o t a l d o P L A e s e u s e s t á g i o s d e p ro c e s s a m e n t o i n d iv i d u a i s A s s o l u ç õ e s , t a m b é m d i s p o n í ve i s c o m o p l a n t a s m o d u l a r e s m o n t a d a s s o b re p l a t a f o r m a s , s u p o r t a m a c o n s t r u ç ã o d e i n s t a l a ç õ e s d e p ro c e s s a m e n t o d e q u a l q u e r t a m a n h o, i n c l u i n d o i n s t a l a ç õ e s d e P L A c o m r e n d i m e n t o s d e a t é 1 0 0 0 0 0 t o n e l a d a s p o r a n o G r a ç a s a e s s a s c a p a c i d a d e s , o s e q u i p a m e n t o s d a S u l z e r e s t ã o p re s e n t e s e m q u a s e t o d a s a s i n s t a l a ç õ e s d e P L A d o mu n d o, p ro p o r c i o n a n d o u m a p ro d u ç ã o e f i c i e n t e e e f i c a z
Para entrar no mercado de PLA e aproveitar as opor tunidades que ele apresenta e competir com sucesso com os f abr icantes de PLA existentes na Ásia e na Amér ica do Nor te, as em presas brasileiras devem selecionar tecnolog ias e instalações comprovadas de processamento Estas podem abor dar um ou mais aspectos e etapas da produção do PLA
A conver são de mater ial vegetal em PLA envolve diferentes etapas Pr imeiro, é preciso fer mentar açúca res de culturas r icas em açúcar para obter o ácido lático (AL) O próximo passo consiste em conver ter o AL em monômeros de lactídeo Esses produ tos inter mediár ios precisam, a seguir, ser pur ificados com equipamentos de destilação e cr istalização antes de so frerem a polimer ização por abe r tura de anel, que resulta no PLA


Além dessas etapas necessár ias do processo, os f abr icantes podem dese jar misturar corantes ou aditivos ao polímero, dependendo da aplicação do produto final Além disso, um peleti
zador de PLA a jusante pode produ zir g rânulos sólidos, simplificando o transpor te e o ar mazenamento É pos sível usar esses g rânulos d e PLA d e vár ias maneiras para atender à aplica ção pretendida Eles podem ser extr u dados em uma folha ou filme, molda dos por injeção, fundidos em folhas, transfor mados em fibras ou até mes mo em espuma Devido ao número de compostos inter mediár ios na f abr icação de bio plásticos à base de PLA, as empresas ag rícolas podem desenvolver suas ca
pacidades em etapas e ao longo do tempo, a fim de aumentarem organi camente as suas operações Por exem plo, é possível começar estabelecendo plantas de produção de AL, que po dem for necer os monômeros para empresas de processamento e distr i buição de AL ou desenvolver lactídeos para unidades de PLA montadas em sistemas modulares Quando o ag ro negócio estiver pronto para crescer, ele poderá implementar todas as seções de processo para as instalações de produ ção ‘da colheita ao PLA’
O Gr upo DND realizou no último 03 de abr il, na cidade de Ser tãozinho SP, um g rande evento de vendas com a temática Rumo ao Topo, a sua pr i meira convenção de vendas anual, momento esse onde pode reunir toda a sua equipe inter na e exter na, apresentando os resultados obtidos ao longo do último ano
Na aber tura do evento, o CEO do Gr upo DND Daniel Fer reira f alou um pouco das expectativas e projeções relacionadas ao ano de 2023/24
“Para nós é de fundamental impor tância a rea lização desta pr imeira convenção de vendas, onde visamos alcançar voos futuros ainda maiores, for ta lecendo e consolidando cada vez mais o nome do Gr upo DND 2023 é um ano de divisão de águas para nós, onde estamos consolidando nosso cresci mento, aumentando nosso cor po de colaboradores, e projetamos um 2024 ainda mais br ilhante E só é possível alcançar o sucesso qualificando, valor izando e motivando à equipe É o Gr upo DND r umo ao topo!”
Apresentando os resultados e f alando um pouco sobre as projeções para os próximos anos, o diretor comercial Lucas Barbosa também destacou a impor tância do evento para as pretensões da empresa

"Esse evento é um divisor de águas para o Gr u po DND, consolidando nossa estratég ia de visão de longo prazo, pois para continuar mos evoluindo e caminhando “Rumo ao Topo”, temos que for tale cer ainda mais as nossas bases, a fim de que tenha mos o supor te necessár io para o crescimento plane jado Por isso, investiremos cada vez mais na for ma ção de equipe, fomentando a autogestão, proativi dade e aprendizagem contínua Juntos, fomos, somos e seremos mais for tes”
O evento contou ainda com um treinamento r ico em conhecimento aplicado pela Fer mentec Academy, ag regando ainda mais conhecimento e qualificação a toda equipe de vendas

Comemorando os resultados e números obtidos ao longo de 2022 foram premiadas equipes inter nas e exter nas que mais se destacaram durante o ano
O gerente comercial Johan Monfils f alou um pouco sobre a impor tância em valor izar os resulta
dos obtidos pela equipe de vendas “Sempre procuro identificar o ponto for te das pessoas, por mais que tenhamos dias difíceis, deixar o clima o melhor possível, buscar a opor tunidade de parabenizar por algo bem feito com capr icho, f azer com que a nossa equipe se sinta par te da organiza ção, da sua impor tância dentro do processo Esta va lor ização das pessoas é peça fundamental para man ter nosso time, reter nossos talentos, que garanto sempre será o sucesso do Gr upo DND”
Finalizando o evento com chave de ouro, onde toda a equipe comercial e administrativa pode assis tir a g rande palestra "Meu Everest" ministrada pelo cr iador dos podcasts "Café Brasil, LíderCast e Café com Leite" com amplo alcance nas redes sociais, Lu ciano Pires, que conta todos os desafios enfrentados ao realizar seu sonho de escalar a montanha mais al ta do mundo, exemplificando como planejamento e metas são imprescindíveis em quaisquer situações
Com 48 anos de atividade a usina espera bater seu recorde de moagem nesta safra, processando 2,8 milhões toneladas de cana
A Usina Pitangueiras promoveu no dia 18 de maio, o Encontro Parceiros do Campo, que além de estreitar as relações com os for necedores, teve como objetivo trazer infor mações técnicas, a fim de auxi liar os produtores em suas tomadas de decisões, vi sando o aumento da produtividade
No evento os consultores Michel Fer nandes da MS Fer nandes, João Rosa (Botão) e Haroldo Tor res, do Pecege, apresentaram as projeções de mercado
Para o presidente da U sina Pitangueiras, João Henr ique de Andrade, “é um evento de g rande im por tância para nossa empresa, para selar essa parce r ia de muitos anos que temos com os nossos for ne cedores, trazendo bastante infor mação pa ra que possamos tomar decisões asser tivas Estamos numa reg ião onde a disputa é muito g rande, então os pro dutores têm que produzir o máximo possível, para diminuir seus custos”
S e g u n d o A n d r a d e, p a r a e s t a s a f r a , a P i t a n g u e i r a s d eve r á m o e r c e rc a d e 2 , 8 m i l h õ e s d e t o n e l a d a s d e c a n a “ E s s a d eve s e r a n o s s a s a f r a re c o rd e, e c o m
o m i x p u x a d o p a r a 7 0 % d e a ç ú c a r ” , i n f o r m o u o p re s i d e n t e
O diretor ag roindustr ial da companhia, Claude mir Leonardo, lembrou que o encontro promovido pela usina foi o pr imeiro no período pós pandemia
“Nosso maior bem é a cana e nós fizemos esse encontro para valor izar cada vez mais nossos parcei ros no campo, nossos for necedores Foi um encon tro muito produtivo e impor tante, por conta do ca lor humano Tivemos também temas técnicos, troca de ideias sobre melhor ias, parcer ias, e vár ias análises para gente inovar e melhorar o setor”, disse Para Fer nando Pinheiro, diretor administrativo da usina, o encontro ating iu seu objetivo ao conse guir englobar e aproximar todos os parceiros e for necedores
O d i re t o r d a P ro C a n a , o j o r n a l i s t a Jo s i a s M e s sias, também presente ao encontro, destaca a trans p a r ê n c i a e a bu s c a d e p a rc e r i a q u e a P i t a n g u e i r a s t e m c o m s e u s f o r n e c e d o re s “ É a l g o i n é d i t o, o n d e m o s t r a a d i s p o s i ç ã o d a u s i n a e m c re s c e r, n ã o a p e n a s e m vo l u m e, m a s e m q u a l i d a d e e p r i n c i p a l m e n t e e m e f i c i ê n c i a M o s t r a t a m b é m a i m p o r t â n c i a d e s s a p a rc e r i a d o g a n h a g a n h a o n d e a u s i n a e s t á f a z e n d o a p a r t e d e l a e e s t á d a n d o u m a o p o r tunidade para o for necedor f azer e ganhar com is s o ” , p o n t u o u M e s s i a s
Em noite memorável, companhia apresentou os resultados e as projeções para os próximos anos
Inteligência Ar tificial, indústr ia 4 0 e transfor mação dig ital são ter mos que, há alguns anos, já estão inser idos no vocabulár io do setor sucroenergé tico, que se encontra cada vez mais aber to à adoção de tecnolog ias inova doras, que avançam nã o somente na produção industr ial e de equipamen tos ag rícolas, como também se expan dem para a gestão de pessoas, como é o caso da utilização do reconheci mento f acial para marcação de ponto

Através da fer ramenta DT Faceum, produzida pela Dimastec, o g r upo At vos deu início, em 2021, ao processo de implantação dessa tecnolog ia, pr imei ramente, em caráter exper imental, em duas unidades, atendendo hoje as 9 usinas da companhia e os 2 escr itór ios cor porativos, distr ibuídos nos estados de São Paulo, Goiás, Mato Grosso e Mato Grosso do Sul


“Planejamos o projeto do reg istro de ponto via reconhecimento f acial para que ocor resse em 2 etapas O pi loto ocor reu em duas usinas do Polo Taquar i e nos escr itór ios de Campi nas e de São Paulo. Nas unidades e no escr itór io de Campinas, implantamos o aplicativo DT Faceum e, no escr i tór io de São Paulo, o DT Faceum web Esse piloto teve seu Go live em setembro de 2022 Em paralelo ao Go live, iniciamos a f ase 2, em que im plantamos o projeto nas sete unidades que compõem os Polos Sul e Goiás”, infor mou Alexandre Lazzar ini, geren te Cor porativo de Projetos da Atvos
Segundo Lazzar ini, a implantação ocor reu dentro do “ novo nor mal” que a pandemia de covid 19 apresentou, com um g rande desafio de mudança de mindset e a adaptação a um mo delo de implantação que rompia por completo com as práticas que existiam até o momento

“Esse desafio foi aceito por todos os par ticipantes do projeto e não pos so deixar de destacar a par ticipação de Sabr ina Castro, Melissa Santos, João Almeida, Adr iano Neves, Rosicleia Alves, Marcelo Santos, seus líderes e li
derados e, por último e não menos impor tante, Wanderlei Lopes, da Di mastec Todos, mesmo com as limita ções que se fizeram presentes por con ta de todo o contexto da pandemia, conseguiram implantar a solução para os mais de 9 000 colaboradores da At vos de maneira satisf atór ia e dentro do cronog rama esperado”, disse
De acordo com Lazzar ini, a solu ção trouxe mais ag ilidade no reg istro do ponto e proporciona um controle mais ativo nas localidades que possuem cober tura de telefonia/Inter net “Mesmo nas localidades mais isoladas, onde trabalhamos no modo off line, conseguimos que os reg istros de pon to fossem atualizados em uma cadên cia maior Outra vantagem impor tan te é a prevenção de fraudes relaciona das ao reg istro do ponto, a utilização do liveness e o geor refe renciamento, que são recur sos impor tantes que uti lizamos”, explicou
Para Dimas Fausto, presidente da Dimastec, concluir a implantação na
Atvos foi um g rande desafio “Finaliza da a negociação comercial, começamos a implantação e, em quatro meses, co locamos o reconhecimento f acial nas 9 unidades e 2 escr itór ios que eles têm espalhados pelo país, inclusive no ad ministrativo de São Paulo Foi um de safio muito g rande porque eles têm mais de 9 mil colaboradores e tínhamos que colocar todas as fotos dentro dos dispositivos, cadastrados numa base única Um g rande diferencial do apli cativo é que ele trabalha offline no campo e per mite que a captura das fo tos dos colaboradores seja feita dessa for ma, facilitando o cadastramento da queles que atuam no campo
Segundo Fausto, outro f ator que também ajudou bastante na hora da instalação do aplicativo em dispositivos nos locais de trabalho e nas áreas de vi vência “Nós desenvolvemos, especial mente para o g rupo Atvos, um suporte que foi sucesso no mercado, que sus tenta tanto celulares quanto tablets É um supor te desenvolvido para toda a
segurança, em metal robusto, que im pede o roubo e também é articulado, o que per mite e f acilita a marcação do reconhecimento facial para pessoas com maior e também com menor estatura” Fausto também ressalta o f ato de o aplicativo trabalhar com prova de vi da “Ele evita que se apres ente uma foto na frente do tablet e ele f aça o re conhecimento Ele dá o feedback pa ra o colaborador se está havendo frau de ou não O nosso aplicativo intera ge com o usuár io também, f alando da possível fraude E é muito rápida a nossa prova de vida Ela f az o reco nhecimento em 3 se gundos e isso também foi um f ator impor tante dentro da cor poração”, explicou De acordo com o presidente da Dimastec, o próximo passo a ser dado dentro da Atvos vai ser integ rar o DT Faceum ao sistema de acesso das ca tracas “Estamos em f ase de testes e homologação Já estamos iniciando esse projeto na unidade Conquista do Pontal, localizada no Oeste Paulista O prog rama trouxe uma economia mui to g rande dentro da cor poração, por que eles tinham mais de 300 equipa mentos que davam uma despesa de manutenção muito g rande e, com a aquisição da nossa platafor ma, redu ziu se drasticamen te o investimento em equipamentos e também as des pesas com manutenção”, infor mou Para Lazzar ini, a Atvos embarcou com força no processo de transfor ma ção dig ital, implantando novas solu ções que ag regarão valor à companhia e, consequentemente, a seus mais de 9 mil colaboradores
A tecnologia reduz custos e traz mais agilidade no registro de ponto dos funcionáriosAplicativo trabalha com prova de vida e evita que se apresente uma foto na frente do tablet para fazer o reconhecimento Dimas Fausto Alexandre Lazzarini
“Hoje cerca de 47% das propr ie dades r urais brasileiras são gerenciadas, lideradas por pessoas com 55 anos ou mais, e isso significa que nos próximos 20 anos nós teremos um processo de sucessão muito for te na propr iedade Então é preciso estabelecer uma go ver nança nessas f amílias, nas propr ie dades, um objetivo de f azer uma tran sição mantendo o nível de produtivi dade, mantendo os níveis de investi mento, de crescimento da produção dessas f amílias”, infor ma Rosemeire Cr istina dos Santos, gerente de rela ções gover namentais da Cor teva Ag r iscience, que em parcer ia com a Organização das Associações de Pro dutores de Cana do Brasil (ORPLA NA) e a FIA Bu siness School, con cluiu a segunda tur ma da Academia de Sucessão no Ag ronegócio, em 11 e 12 de maio, na sede da ORPLANA, em Ribeirão Preto SP
Segundo José Guilher me No gueira, CEO da ORPLANA, a ques tão da sucessão no ag ronegócio é um g rande gargalo do setor e uma preo cupação constante da ORPLANA “Assim, ter o olhar direcionado para o
futuro dos negócios é o g rande dife rencial da Academia de Sucessão no Ag ronegócio E ver mais uma tur ma de jovens sucessores da produção de cana de açúcar for mada, além de preparada e integ rada aos negócios da f amília, é olhar para o futuro do setor sucroenergético com a cer teza de no vos caminhos e inúmeras opor tunida des”, afir ma

Nogueira explica que esse prog ra ma de sucessão, f az par te de uma sér ie de ações que a ORPLANA vem rea lizando para garantir a longevidade das propr iedades e um futuro rentável aos produtores “Sucessão é um assunto espinhoso, não é simples a definição de herdeiro, definição de sucessor, de quem que vai tocar o negócio, como vai tocar, definir os papéis e responsa bilidade dos filhos Para auxiliar a di r imir essas questões, fir mamos essa parcer ia com a Cor teva, que promo veu o cur so ” , explicou
A iniciativa contou com 28 alunos e tem o propósito de contr ibuir para a capacitação de jovens de f amílias em presár ias do setor de cana de açúcar, auxiliando os no processo de sucessão f amiliar
N o eve n t o, o s s u c e s s o re s d o s p ro d u t o re s a s s o c i a d o s à O R P L A N A q u e j á a t u a m n a p ro p r i e d a d e f a m i l i a r a p re s e n t a r a m s e u s t r a b a l h o s d e c o n c l u s ã o d e c u r s o N a s a p re s e n t a ç õ e s , q u e c o n t a r a m c o m a p re s e n ç a d o s f a m i l i a re s e d a b a n c a f o r m a d a p o r
p ro f e s s o re s d a F I A B u s i n e s s S c h o o l e re p re s e n t a n t e s d a C o r t eva e d a O R
P L A N A , d e s t a c a r a m s u a s h i s t ó r i a s e c o n t e x t u a l i z a r a m o s e u n e g ó c i o f a m i l i a r, a s i t u a ç ã o d a o r g a n i z a ç ã o e o s próximos passos que devem seguir na s u c e s s ã o
Ao longo dos sete meses da Aca demia de Sucessão no Ag ronegócio, de outubro de 2022 a maio de 2023, os alunos integ raram aulas on line e ao vivo ministradas por docentes da FIA FIA Business School O cu r so abor dou os temas da gover nança nas em presas de controle f amiliar e os desa fios da sucessão, a gestão financeira voltada para os sócios desse perfil de empresa, os modelos de planejamento societár io e tr ibutár io para proteger o patr imônio da f amília, as competên cias compor tamentais e sua relação com o processo decisór io e novos di recionadores do ambiente de negó cios, como inovação e prática ESG
“For mar a segunda tur ma da Aca demia de Sucessão no Ag ronegócio é ter a cer teza de que estamos contr i buindo para um futuro mais sustentá vel e ajudando também na for mação de uma nova geração de líderes, co nectada ao desafio de sucessão f ami liar do setor canavieiro São 28 novos líderes que estão constr uind o juntos suas trajetór ias e de suas f amílias, dan do segmento a um negócio que foi iniciado há décadas pelos avós ou pais e, hoje caminham r umo a um futuro
mais sustentável e próspero. É g ratifi cante ver o plano e o crescimento de cada um após os sete meses de capa citação”, celebra Redson Vieira, Líder Comercial da linha cana de açúcar da Cor teva
“A Academia de Sucessão é um ambiente de aprendizagem e cons cientização da impor tância da gover nança e do planejamento sucessór io, bem como de um conjunto de fer ra mentas para a cr iação de valor susten tável para o negócio ao longo das di versas gerações O pr incipal diferencial do prog rama está na aprendizagem co letiva, com a troca de exper iências en tre as f amílias empresár ias na busca por soluções para problemas em comum a par tir de uma base conceitual sólida, além da possibilidade de ampliarem seu networking positivo”, comenta o pro fessor Claudio A Pinheiro Machado Filho, da FIA Business School
Um dos par ticipantes do cur so destaca a impor tância do aprendizado complementar “Comecei a f azer o cur so justamente para complementar todo o conhecimento que a gente já tem na prática A gente não pensa em todos os detalhes, então um cur so co mo esse ag rega muito para ter uma vi são de fora, do que se pode trazer pa ra dentro Tem a par te de finanças, da gestão f amiliar, o olhar para os desafios futuros, e tem a questão da gestão es tratég ica que também pode auxiliar na gestão do dia a dia”, complementa
A 2ª turma da Academia de Sucessão no Agronegócio contou com 28 par ticipantes
IAC de Qualidade de Equipamentos de Proteção Individual ou EPI na Ag r icultura (IAC Quepia) Esta ini ciativa une a ind ústr ia da área ao Centro de Engenhar ia e Automação (CEA), do Instituto Ag ronômico (IAC), órgão da Secretar ia de Ag r i cultura e Abastecimento do Estado de SP, em Jundiaí

R a m o s a c re s c e n t a a i n d a q u e o p rog r a m a I AC Q u e p i a s e d e d i c a , n o s d i a s d e h o j e, a u m a s é r i e d e e s t u d o s c o m p l e m e n t a re s e m t o r n o d a s e l e ç ã o d e m a t é r i a s p r i m a s c a p a z e s d e re d u z i r a e x p o s i ç ã o d o a p l i c a d o r d e a g ro t ó x i c o s
A nor ma ABNT NBR ISO 27065 foi disponibilizada no final de abr il e ver sa sobre os requisitos de de sempenho para vestimentas protetivas produzidas no país, empregadas por trabalhadores r urais aplicadores de ag rotóxicos A publicação foi possível após intenso trabalho da C E 32:006 03 (Comissão de Estudos de Luvas e Vestimentas de Proteção/Ris cos Químicos), composta por entida des, pesquisadores e empresas
“Na prática, os estudos que deram or igem à pr imeira ver são dessa nor ma tiveram início em 2004”, destaca o pesquisador científico Hamilton Ra mos, membro da comissão de estudos e também coordenador do prog rama
Ramos é considerado no Brasil um dos precur sores da inovação atrelada à qualidade dos EPI Representantes das indústr ias de ag rotóxicos e EPI, por exemplo, atr ibuem a ele par te da res ponsabilidade pela evolução tecnoló g ica das vestimentas e de luvas prote tivas para aplicadores de ag rotóxicos
O pesquisador figura desde 2004 como membro do Comitê Técnico ABNT/CB 032, que conduziu esfor ços e iniciativas de pesquisas com vis tas ao apr imoramento da nor ma ISO 27065 O conteúdo de base do novo documento, complementa Ramos, abrange requisitos de desempenho, classificação e etiquetagem para vesti mentas protetivas utilizadas no manu seio de ag rotóxicos (fung icidas, her bicidas, inseticidas e outros)

“Auxiliamos à indústr ia do setor a buscar cer tificações baseadas nas nor mas da ISO para esses produtos”, re força Ramos Interligado a um Con sórcio for mado por oito países, in cluindo Estados Unidos, França, Ale manha e Eslovênia, o prog rama IAC Quepia for nece um selo própr io, o “Selo Quepia”, a f abr icantes de EPI que atendam parâmetros de seguran ça, resistência e qualidade de tecidos, confor me ressalta o pesquisador
Cr iado há 17 anos, “ por isso deten tor de um acervo altamente qualificado na área de estudos sobre EPI”, diz Ra mos, o prog rama IAC Quepia reduziu as reprovações de qualidade de vesti mentas protetivas agrícolas fabr icadas no Brasil, que em 2010 eram da ordem de 80% do montante analisado no labora tór io de Jundiaí SP Hoje, celebra ele, esse número é infer ior a 20%

Conteúdo versa sobre requisitos de desempenho das vestimentas protetivas para aplicadores de agrotóxicos

O Sindicato Nacional das Empre sas de Aviação Ag rícola (Sindag) pro tocolou junto ao Supremo Tr ibunal Federal (STF) seus embargos de de claração contra o julgamento que de cidiu pela constitucionalidade da lei do Ceará que proibiu o uso da fer ra menta aérea no trato de lavouras na quele Estado
O Sindag figura no processo como amicus cur iae – terceiro interessado, cujo conhecimento ou relação com o debate pode contr ibuir com a discus são
A própr ia CNA também apresen tou embargos apontando inconsistên cias no relatór io da ministra Car mem
Lúcia Assim como o Sindicato Na cional dos Aeronautas (SNA), que abrange os pilotos e bateu pr incipal mente na tecla de que a lei cearense, ao proibir integ ralmente a aviação ag rí cola, foi contra o pr incípio constitu cional do direito social ao trabalho
Já a Associação Brasileira dos Pro dutores e Expor tadores de Fr utas e Der ivados (Abrafr utas, também ami cus cur iae no processo) destacou que não foi intimada da sessão de julga mento O que lhe impediu de solici tar sustentação oral de seus argumen tos durante o julgamento
Em sua argumentação, o Sindag contesta diver sos pontos do relatór io apresentado pela ministra Car mem Lúcia – e que embasaram a decisão do coleg iado da casa Entre eles a citação de ar tigo que se refere a pesquisas da Embrapa que comprovar iam a impre cisão das aplicações aéreas Sendo que o trabalho citado é, na verdade, o re cor te do ar tigo de 2013, de uma ad vogada doutora em direito que se re fere a um trabalho de 2004 onde está citada uma pesquisa de 1999, que ge rou ar tigos sobre eventuais r iscos em todas as aplicações
A o p a s s o q u e, n o t r a b a l h o d e 2 4 anos atrás, a pesquisa na verdade ava l i a c o m o ev i t a r a d e r iva d e t o d o s o s m e i o s d e a p l i c a ç ã o – e n ã o c i t a a av i a ç ã o p ro p r i a m e n t e c o m o r i s c o E m c o n t r a p a r t i d a , e m
E m b r a p a e m i t i u n o t a re f e re n t e a p e s q u i s a s re a l i z a d a s e n t re 2 0 1 5 e 2 0 1 7 a t e s t a n d o a s e g u r a n ç a d a s a p l i c a ç õ e s a é re a s
A lista de apontamentos do Sindag abrange também a referência de uma declaração de 2005 da Or ganização Inter nacional do Trabalho (OIT), de que os ag rotóxicos (sem referência a meio de aplicação) causar iam anual mente (no mundo todo) 70 mil into xicações agudas e crônicas que evo luem para óbito Onde o Sindag sus tenta que essa não é uma realidade da aviação ag rícola, que é o único meio de aplicação de ag rotóxicos no Brasil com regulamentação própr ia e exten sa, exig indo, por exemplo, que prati camente todos os envolvidos nas ope rações em campo sejam no mínimo técnicos – piloto ag rícola com for ma ção especial, obr igator iedade de en
genheiro ag rônomo coordenando ca da operação e de técnico ag rícola com especialização com especialização em operação aérea no trabalho de apoio em solo ao avião

Nesse ponto, o sindicato aeroag rí cola embasou o raciocínio com dados do própr io Censo Ag ro do IBGE, que em 2006 mo strou que, naquele ano, 973 mil propr iedades r urais no país ti veram aplicações de ag rotóxicos com pulver izadores costais (com o aplica dor a pé na lavoura) Ao passo que outras 379 mil propr iedades tiveram aplicações com tratores, 74 mil com pulver izador estacionár io e apenas 10 mil tiveram aplicações aéreas
Já em 2017, o Censo Ag ro mostrou que 15,6% dos produtores que utiliza ram ag rotóxicos no Brasil não sabiam ler e escrever e, destes, 89% declararam não ter recebido qualquer tipo de
or ientação técnica Enquanto, dos produtores alf abetizados que utilizam ag rotóxicos no país, 69,6% possuíam no máximo o ensino fundamental e, entre eles, apenas 30,6% declararam ter recebido or ientação técnica a respeito da aplicação do produto
O re l a t ó r i o a p rova d o p e l o s m i n i s t ro s t a m b é m f a z re f e r ê n c i a a u m d o s s i ê d a A s s o c i a ç ã o B r a s i l e i r a d e S a ú d e C o l e t iva ( A b r a s c o ) , q u e p o r s u a ve z a s s i n a l a q u e “ u m t e r ç o d o s a l i m e n t o s c o n s u m i d o s c o t i d i a n a mente pelos brasileiros está contami nado pelos ag rotóxicos”, baseado no Prog rama de Análise de Resíduos de A g ro t ó x i c o s e m A l i m e n t o s ( PA R A ) d a A g ê n c i a N a c i o n a l d e V i g i l â n c i a Sanitár ia (Anvisa)
Só que, ao analisar os relatór ios do PARA, justamente os alimentos com resultados positivos para contamina ç ã o s ã o o r i u n d o s d e c u l t u r a s n ã o atendidas pela aviação ag rícola, espe cialmente hor taliças E o maior indi cativo desse er ro está no ar roz: justa mente a lavoura onde mais de 70% de s u a s á re a s s ã o a t e n d i d a s p e l a av i a ç ã o ag rícola no país aparece com conta m i n a ç ã o z e ro e m t o d o s o s a n o s d o levantamento
Confor me o diretor executivo do Sindag, Gabr iel Colle, o relatór io da entidade deixa claro que a lei aprova da na última sessão do ano a Assem bleia Leg islativa cearense em 2018 e que entrou em vigor em 2019, foi ba seada muito mais no preconceito con tra a aviação ag rícola do que na reali dade sobre a segurança em campo
Entidade aponta contradições em pesquisas e ar tigos nos quais se baseou o relatório aprovado no julgamento encerrado em 29 de maio

